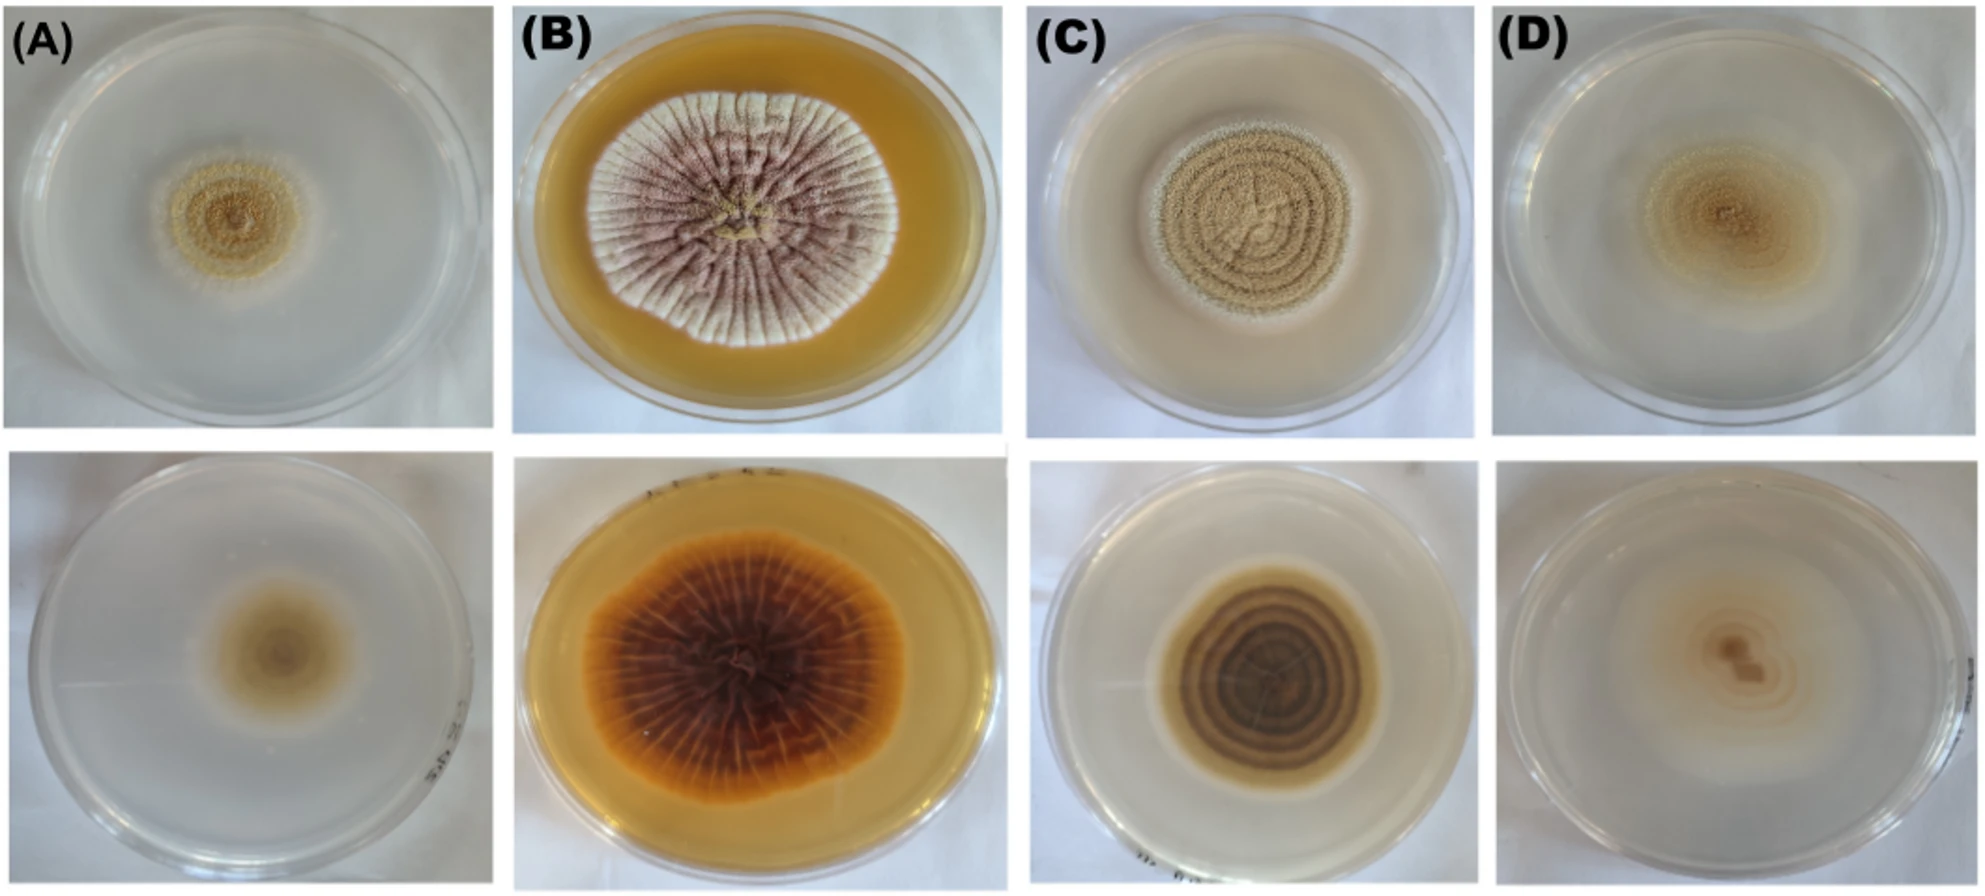

Publications
2026
| 290 | “An Integrative Genomic and Chemical Similarity Approach Linking Fungal Secondary Metabolites and Biosynthetic Gene Clusters.” Karin Steffen, Manuel Rangel-Grimaldo, Thomas J C Sauters, David C Rinker, Huzefa A Raja, Tyler N Graf, Adiyantara Gumilang, Olivia L Riedling, Gustavo H Goldman, Nicholas H Oberlies, Antonis Rokas Organic & Biomolecular Chemistry, 2026, 24, 1323-1338. PMID: 41568590; doi: 10.1039/D5OB01965F | ![]() |
2025
| 289 | “An antimicrobial daptide from human skin commensal Staphylococcus hominis protects against skin pathogens.” Amber Nguyen, Zoie L. Bunch, Ingrid Y. Martinez-Aldino, Manuel Rangel-Grimaldo, Uday Tak, John C. Thorstenson, Morgan M. Severn, Teruaki Nakatsuji, Richard L. Gallo, Tyler N. Graf, Nicholas H. Oberlies, Jonathan R. Chekan, Nadja B. Cech, and Alexander R. Horswill Nature Communications, 2025, 16, 11459. PMID: 41381538; PMCID: PMC12749797; doi: 10.1038/s41467-025-66259-w | |
| 288 | “Beyond Monomers: Discovery of Bioactive Naphthoquinone Heterodimers and Perenniporides from Pyrenochaetopsis Species.” Reema A. Al-Qiam, Manuel Rangel-Grimaldo, Isabel M. Chauvin, Elizabeth N. Kaweesa, Manead Khin, Huzefa A. Raja, Jimmy Orjala, Joanna E. Burdette, Cedric J. Pearce, and Nicholas H. Oberlies Journal of Natural Products, 2025, 88, 2968-2977. PMID: 41328757; PMCID: PMC12751106; doi: 10.1021/acs.jnatprod.5c01209 | ![]() |
| 287 | “Natural pigments from the endophyte Aspergillus westerdijkiae and evaluation of their bioactivities.” Abirami Baskaran, Andreas Wasilewicz, Judith M. Rollinger, Joanna Grzelczyk, Ilona Gałązka-Czarnecka, Grażyna Budryn, Tomasz Strzała, Tyler N. Graf, Nicholas H. Oberlies, Filip Boratyński, and El-Sayed R. El-Sayed Microbial Cell Factories, 2025, 25, 32. PMID: 41476306; PMCID: PMC12865964; doi: 10.1186/s12934-025-02905-8 | ![]() |
| 286 | “Studying the Molecular Mechanisms of Tef (Eragrostis tef) Antioxidant Properties in Human THP-1 Monocytes.” Anastasia V. Romanov, Tyler N. Graf, Warren Vidar, Dereje D. Jima, Nicholas H. Oberlies, Zhenquan Jia, and Ayalew Ligaba-Osena Journal of Functional Foods, 2025, 135, 107092. doi: 10.1016/j.jff.2025.107092 | ![]() |
| 285 | “Machine-Readable Structural Information Is Essential for Natural Products Research.” Karin Steffen, Nicholas H. Oberlies, and Antonis Rokas Journal of Natural Products, 2025, . PMID: 41114445; doi: 10.1021/acs.jnatprod.5c00836 | ![]() |
| 284 | “Scaling Up the Production of Fungal Perylenequinones and Investigating Their Biosynthesis Through Stable Isotope Labeling.” Reema A. Al-Qiam, Sachin Dumbare, Tyler N. Graf, Warren S. Vidar, Huzefa A. Raja, Cedric J. Pearce, Shabnam Hematian, and Nicholas H. Oberlies Microbial Cell Factories, 2025, 24, 213. PMID: 41044762; PMCID: PMC12492911; doi: 10.1186/s12934-025-02842-6 | ![]() |
| 283 | “Redox Homeostasis as a Key Regulator of Intramolecular Cyclization in Fungal Perylenequinones.” Reema A. Al-Qiam, Firoz S. T. Khan, Huzefa A. Raja, Tyler N. Graf, Cedric J. Pearce, Nicholas H. Oberlies, and Shabnam Hematian ACS Chemical Biology, 2025, 20, 2063-2068. PMID: 40793773; PMCID: PMC12455569; doi: 10.1021/acschembio.5c00369 | ![]() |
| 282 | “The Importance of Verifying Biological Activity Predictions in Metabolomics Studies of Natural Products: A Case Study on Antimicrobial Properties of Cannabis sativa (Hemp).” Fridah C. Rotich, Joseph B. Mangun, Joëlle Houriet, Warren S. Vidar, Tyler N. Graf, Nicholas H. Oberlies, and Nadja B. Cech Phytochemistry Letters, 2025, 68, 103014. doi: 10.1016/j.phytol.2025.103014 | ![]() |
| 281 | “Fungal Planet Description Sheets: 1781–1866.” PW Crous, DEA Catcheside, PS Catcheside, AC Alfenas, RF Alfenas, RW Barreto, T Lebel, S Balashov, J Broadbridge, Ž Jurjević, S De la Peña-Lastra, R Hoffmann, A Mateos, J Riebesehl, RG Shivas, FF Soliz Santander, YP Tan, A Altés, D Bandini, F Carriconde, J Cazabonne, P Czachura, H Gryta, G Eyssartier, E Larsson, OL Pereira, A Rigueiro-Rodríguez, MJ Wingfield, W Ahmad, S Bibi, S Denman, F Esteve-Raventós, S Hussain, T Illescas, JJ Luangsa-ard, L Möller, A Mombert, W Noisripoom, I Olariaga, F Pancorbo, A Paz, M Piątek, C Polman-Short, E Suárez, NS Afshan, H Ali, M Arzanlou, F Ayer, J Barratt, J-M Bellanger, A Bidaud, SL Bishop-Hurley, M Bohm, T Bose, E Campo, NB Chau, ÖF Çolak, TRL Cordeiro, MO Cruz, FA Custódio, A Couceiro, V Darmostuk, JDW Dearnaley, ALCM de Azevedo Santiago, LWS de Freitas, M de J Yáñez-Morales, C Domnauer, B Dentinger, K Dhileepan, JT De Souza, F Dovana, U Eberhardt, P Eisvand, A Erhard, V Fachada, A García-Martín, M Groenewald, A Hammerbacher, K Harms, S Haroon, M Haqnawaz, S Henriques, AJ Hernández, LM Jacobus, D Jaen-Contreras, P Jangsantear, O Kaygusuz, R Knoppersen, TKA Kumar, MJ Lynch, R Mahiques, GL Maraia, PAS Marbach, M Mehrabi-Koushki, PR Miller, S Mongkolsamrit, P-A Moreau, NH Oberlies, JA Oliveira, D Orlovich, AS Pérez-Méndez, A Pinto, HA Raja, GH Ramírez, B Raphael, A Rodrigues, H Rodrigues, DO Ramos, A Safi, S Sarwar, I Saar, RM Sánchez, JS Santana, J Scrace, LS Sales, LNP Silva, M Stryjak-Bogacka, A Tacconi, VN Thanh, A Thomas, NT Thuy, M Toome, JM Valdez-Carrazco, NI van Vuuren, J Vasey, J Vauras, C Vila-Viçosa, M Villarreal, CM Visagie, A Vizzini, EJ Whiteside, and JZ Groenewald Persoonia, 2025, 54, 327-587. doi: 10.3114/persoonia.2025.54.10 | ![]() |
| 280 | “Studies on the Epipolythiodioxopiperazine Alkaloid Verticillin D: Scaled Production, Streamlined Purification, and Absolute Configuration.” Herma C Pierre, Devyani J Patel, Huzefa A Raja, Blaise A Darveaux, Krupa I Patel, Lina Mardiana, Alexandra Longcake, Michael J Hall, Michael R Probert, Cedric J Pearce, and Nicholas H Oberlies Phytochemistry, 2025, 236, 114492. PMID: 40147592; doi: 10.1016/j.phytochem.2025.114492 | ![]() |
| 279 | “A Gut Response: Application of Human Enteroid Monolayers to Probe the Mechanism of the Goldenseal-Mediated Inhibition of Metformin Intestinal Absorption.” Christopher M Arian, Eimear T O’Mahony, Preston K Manwill, Tyler N Graf, Nicholas H Oberlies, Nadja B Cech, John D Clarke, Jason G Smith, Mary F Paine, Edward J Kelly, and Kenneth E Thummel The Journal of Pharmacology and Experimental Therapeutics, 2025, 392, 103957. PMID: 40403579; doi: 10.1016/j.jpet.2025.103597 | ![]() |
| 278 | “Menominin A and B: Cytotoxic Cyclodepsipeptides from the Freshwater Sponge-Associated Cyanobacterium Nostoc sp. UIC 10607.” Lydia J Davis, Aleksej Krunić, Kelsey Alexander, Manead Khin, Jared S Wood, Cody Earp, Manuel Rangel-Grimaldo, Alessandra S Eustáquio, Joanna E Burdette, R Thomas Williamson, Nicholas H Oberlies, and Jimmy Orjala Journal of Natural Products, 2025, 88, 732-746. PMID: 39977243; PMCID: PMC11952978; doi: 10.1021/acs.jnatprod.4c01445 | ![]() |
| 277 | “Verticillin A-Loaded Surgical Buttresses Prevent Local Pancreatic Cancer Recurrence in a Murine Model.” Zeinab Y. Al Subeh, Herma C. Pierre, Cedric J. Pearce, Mark W. Grinstaff, Aaron H. Colby, Kebin Liu, and Nicholas H. Oberlies Molecular Pharmaceutics, 2025, 22, 1220-1229. PMID: 39868439; PMCID: PMC11881038; doi: 10.1021/acs.molpharmaceut.4c00589 | ![]() |
2024
| 276 | “Fungal Planet Description Sheets: 1697-1780.” PW Crous, MJ Wingfield, Ž Jurjević, S Balashov, ER Osieck, Y Marin-Felix, JJ Luangsa-ard, LC Mejía, A Cappelli, LA Parra, G Lucchini, J Chen, G Moreno, M Faraoni, RL Zhao, Ø Weholt, J Borovička, GM Jansen, RG Shivas, YP Tan, A Akulov, AC Alfenas, RF Alfenas, A Altés, R Avchar, RW Barreto, DEA Catcheside, TY Chi, F Esteve-Raventós, SC Fryar, LTM Hanh, J Larsbrink, NH Oberlies, L Olsson, F Pancorbo, HA Raja, VN Thanh, NT Thuy, K Ajithkumar, W Akram, P Alvarado, B Angeletti, E Arumugam, A Atashi Khalilabad, D Bandini, TJ Baroni, GG Barreto, D Boertmann, T Bose, RF Castañeda Ruiz, A Couceiro, B Cykowska-Marzencka, YC Dai, V Darmostuk, SBG da Silva, JDW Dearnaley, ALCM de Azevedo Santiago, B Declercq, LWS de Freitas, S De la Peña-Lastra, G Delgado, CLF de Lima, D Dhotre, AC Dirks, P Eisvand, A Erhard, LO Ferro, D García, A García-Martín, I Garrido-Benavent, J Gené, M Ghobad-Nejhad, G Gore, S Gunaseelan, LFP Gusmão, A Hammerbacher, AT Hernández-Perez, M Hernández-Restrepo, TA Hofmann, V Hubka, N Jiya, M Kaliyaperumal, KS Keerthana, M Ketabchi, K Kezo, R Knoppersen, D Kolarczyková, TKA Kumar, T Læssøe, E Langer, E Larsson, DJ Lodge, MJ Lynch, JG Maciá-Vicente, S Mahadevakumar, A Mateos, M Mehrabi-Koushki, BV Miglio, A Noor, JA Oliveira, OL Pereira, M Piątek, A Pinto, GH Ramírez, B Raphael, G Rawat, M Renuka, K Reschke, A Ruiz Mateo, I Saar, M Saba, A Safi, RM Sánchez, M Sandoval-Denis, AS Savitha, A Sharma, D Shelke, H Sonawane, MGAP Souza, M Stryjak-Bogacka, M Thines, A Thomas, D Torres-Garcia, JM Traba, J Vauras, M Vermaas, M Villarreal, D Vu, EJ Whiteside, D Zafari, M Starink-Willemse, and JZ Groenewald Fungal Systematics and Evolution, 2024, 14, 325-577. PMID: 39830292; PMCID: PMC11736264; doi: 10.3114/fuse.2024.14.19 | ![]() |
| 275 | “Evolutionary Origin and Population Diversity of a Cryptic Hybrid Pathogen.” Jacob L. Steenwyk, Sonja Knowles, Rafael W. Bastos, Charu Balamurugan, David Rinker, Matthew E. Mead, Christopher D. Roberts, Huzefa A. Raja, Yuanning Li, Ana Cristina Colabardini, Patrícia Alves de Castro, Thaila Fernanda dos Reis, Adiyantara Gumilang, María Almagro-Molto, Alexandre Alanio, Dea Garcia-Hermoso, Endrews Delbaje, Laís Pontes, Camila Figueiredo Pinzan, Angélica Zaninelli Schreiber, David Canóvas, Rafael Sanchez Luperini, Katrien Lagrou, Egídio Torrado, Fernando Rodrigues, Nicholas H. Oberlies, Xiaofan Zhou, Gustavo H. Goldman, and Antonis Rokas Nature Communications, 2024, 15, 8412. PMID: 39333551; PMCID: PMC11436853; doi: 10.1038/s41467-024-52639-1 | ![]() |
| 274 | “Phylogenomics Reveals Extensive Misidentification of Fungal Strains from the Genus Aspergillus.” Jacob L. Steenwyk, Charu Balamurugan, Huzefa A. Raja, Carla Gonçalves, Ningxiao Li, Frank Martin, Judith Berman, Nicholas H. Oberlies, John G. Gibbons, Gustavo H. Goldman, David M. Geiser, Jos Houbraken, David S. Hibbett, and Antonis Rokas Microbiology Spectrum, 2024, 12, e0398023 PMID: 38445873; PMCID: PMC10986620; doi: 10.1128/spectrum.03980-23 | ![]() |
| 273 | “Bioactivity‑Driven Fungal Metabologenomics Identifies Antiproliferative Stemphone Analogs and Their Biosynthetic Gene Cluster.” Navid J. Ayon, Cody E. Earp, Raveena Gupta, Fatma A. Butun, Ashley E. Clements, Alexa G. Lee, David Dainko, Matthew T. Robey, Manead Khin, Lina Mardiana, Alexandra Longcake, Manuel Rangel‑Grimaldo, Michael J. Hall, Michael R. Probert, Joanna E. Burdette, Nancy P. Keller, Huzefa A. Raja, Nicholas H. Oberlies, Neil L. Kelleher, and Lindsay K. Caesar Metabolomics, 2024, 20:90 PMID: 39095664; PMCID: PMC11296971; doi: 10.1007/s11306-024-02153-8 | ![]() |
| 272 | “Green Tea Catechins Decrease Solubility of Raloxifene In Vitro and Its Systemic Exposure in Mice.” Victoria O. Oyanna, Baron J. Bechtold, Katherine D. Lynch, M. Ridge Call, Tyler N. Graf, Nicholas H. Oberlies, and John D. Clarke Pharmaceutical Research, 2024, 41, 557-566. PMID: 38302834; PMCID: PMC10939713; doi: 10.1007/s11095-024-03662-w | ![]() |
| 271 | “Wheldone Revisited: Structure Revision Via DFT-GIAO Chemical Shift Calculations, 1,1-HD-ADEQUATE NMR Spectroscopy, and X‑ray Crystallography Studies.” Manuel Rangel-Grimaldo, Cody E. Earp, Huzefa A. Raja, Jared S. Wood, Lina Mardiana, Kin Lok Ho, Alexandra Longcake, R. Thomas Williamson, Lukáš Palatinus, Michael J. Hall, Michael R. Probert, and Nicholas H. Oberlies Journal of Natural Products, 2024, 87, 2095-2100. PMID: 39039966; PMCID: PMC11348420; doi: 10.1021/acs.jnatprod.4c00649 | ![]() |
| 270 | “Strain Heterogeneity in a Non-Pathogenic Aspergillus Fungus Highlights Factors Associated with Virulence.” David C. Rinker, Thomas J. C. Sauters, Karin Steffen, Adiyantara Gumilang, Huzefa A. Raja, Manuel Rangel-Grimaldo, Camila Figueiredo Pinzan, Patrícia Alves de Castro, Thaila Fernanda dos Reis, Endrews Delbaje, Jos Houbraken, Gustavo H. Goldman, Nicholas H. Oberlies, and Antonis Rokas Communications Biology, 2024, 7, 1082. PMID: 39232082; PMCID: PMC11374809; doi: 10.1038/s42003-024-06756-8 | ![]() |
| 269 | “Verticillins: Fungal Epipolythiodioxopiperazine Alkaloids with Chemotherapeutic Potential.” Herma C. Pierre, Chiraz Soumia M. Amrine, Michael G. Doyle, Amrita Salvi, Huzefa A. Raja, Jonathan R. Chekan, Andrew C. Huntsman, James R. Fuchs, Kebin Liu, Joanna E. Burdette, Cedric J. Pearce, and Nicholas H. Oberlies Natural Product Reports, 2024. PMID: 38629495; doi: 10.1039/d3np00068k | ![]() |
| 268 | “Neosetophomone B Induces Apoptosis in Multiple Myeloma Cells via Targeting of AKT/SKP2 Signaling Pathway.” Shilpa Kuttikrishnan, Fareed Ahmad, Jericha M. Mateo, Kirti S. Prabhu, Tamam El‐Elimat, Nicholas H. Oberlies, Cedric J. Pearce, Ammira S. Alshabeeb Akil, Ajaz A. Bhat, Feras Q. Alali, and Shahab Uddin Cell Biology International, 2024, 48, 190-200. PMID: 37885161; PMCID: PMC10952688; doi: 10.1002/cbin.12101 | ![]() |
| 267 | “Rifampin- and Silymarin-Mediated Pharmacokinetic Interactions of Exogenous and Endogenous Substrates in a Transgenic OATP1B Mouse Model.” Baron J. Bechtold, Katherine D. Lynch, Victoria O. Oyanna, M. Ridge Call, Tyler N. Graf, Nicholas H. Oberlies, and John D. Clarke Molecular Pharmaceutics, 2024, 21, 2284-2297. PMID: 38529622; PMCID: PMC11073900; doi: 10.1021/acs.molpharmaceut.3c01088 | ![]() |
| 266 | “Pharmacokinetic Effects of Different Models of Nonalcoholic Fatty Liver Disease in Transgenic Humanized OATP1B Mice.” Baron J. Bechtold, Katherine D. Lynch, Victoria O. Oyanna, M. Ridge Call, Laura A. White, Tyler N. Graf, Nicholas H. Oberlies, and John D. Clarke Drug Metabolism and Disposition, 2024, 52, 355-367. PMID: 38485280; PMCID: PMC11023818; doi: 10.1124/dmd.123.001607 | |
| 265 | “Semisynthesis, Characterization, and Biological Evaluation of Fluorinated Analogues of the Spirobisnaphthalene, Diepoxin-η.” Hadi Pourhadi, Tamam El-Elimat, Manuel Rangel-Grimaldo, Tyler N. Graf, Joseph O. Falkinham III, Manead Khin, Joanna E. Burdette, Nathan Mirtallo Ezzone, Jonathan G. Jeyaraj, Esperanza Carcache de Blanco, Cedric J. Pearce, and Nicholas H. Oberlies Tetrahedron Letters, 2024, 134, 154857 PMID: 38328000; PMCID: PMC10846677; doi: 10.1016/j.tetlet.2023.154857 | ![]() |
| 264 | “Exploring the in vivo Anti-Cancer Potential of Neosetophomone B in Leukemic Cells Using a Zebrafish Xenograft Model.” Shilpa Kuttikrishnan, Maram Hasan, Kirti S. Prabhu, Tamam El-Elimat, Nicholas H. Oberlies, Cedric J. Pearce, Feras Q. Alali, Aamir Ahmad, Ehsan Pourkarimi, Ajaz A. Bhat, Huseyin C. Yalcin, and Shahab Uddin Experimental Cell Research, 2024, 435, 113907 PMID: 38184222; doi: 10.1016/j.yexcr.2023.113907 | ![]() |
| 263 | “Semisynthetic Derivatives of the Fungal Metabolite Eupenifeldin via Targeting the Tropolone Hydroxy Groups.” Zeinab Y. Al Subeh, Herma C. Pierre, Ross H. Bockbrader, Robert J. Tokarski II, Amanda C. Maldonado, Monica A. Haughan, Manuel E. Rangel-Grimaldo, Cedric J. Pearce, Joanna E. Burdette, James R. Fuchs, and Nicholas H. Oberlies Bioorganic & Medicinal Chemistry Letters, 2024, 110, 129875 PMID: 38964520; PMCID: PMC11369961; doi: 10.1016/j.bmcl.2024.129875 | ![]() |
2023
| 262 | “Radiolabeled Biodistribution of Expansile Nanoparticles: Intraperitoneal Administration Results in Tumor Specific Accumulation.” Aaron H. Colby, Jack Kirsch, Amit N. Patwa, Rong Liu, Beth Hollister, William McCulloch, Joanna E. Burdette, Cedric J. Pearce, Nicholas H. Oberlies, Yolonda L. Colson, Kebin Liu, and Mark W. Grinstaff ACS Nano, 2023, 17, 2212-2221. PMID: 36701244; PMCID: PMC9933882; doi: 10.1021/acsnano.2c08451 | ![]() |
| 261 | “Clinical Assessment of the Drug Interaction Potential of the Psychotropic Natural Product Kratom.” Rakshit S. Tanna, James T. Nguyen, Deena L. Hadi, Matthew E. Layton, John R. White, Nadja B. Cech, Nicholas H. Oberlies, Allan E. Rettie, Kenneth E. Thummel, and Mary F. Paine Clinical Pharmacology & Therapeutics, 2023, 113, 1315-1325. PMID: 36924284; PMCID: PMC10198846; doi: 10.1002/cpt.2891 | ![]() |
| 260 | “Exploration of Verticillins in High-Grade Serous Ovarian Cancer and Evaluation of Multiple Formulations in Preclinical in Vitro and in Vivo Models.” Elizabeth N. Kaweesa, Jaqueline M. Bazioli, Herma C. Pierre, Daniel D. Lantvit, Samuel K. Kulp, Kasey L. Hill, Mitch A. Phelps, Christopher C. Coss, James R. Fuchs, Cedric J. Pearce, Nicholas H. Oberlies, and Joanna E. Burdette Molecular Pharmaceutics, 2023, 20, 3049-3059. PMID: 37155928; PMCID: PMC10405366; doi: 10.1021/acs.molpharmaceut.3c00069 | ![]() |
| 259 | “Trachymyrmex septentrionalis Ants Promote Fungus Garden Hygiene Using Trichoderma-Derived Metabolite Cues.” Kathleen E. Kyle, Sara P. Puckett, Andrés Mauricio Caraballo-Rodríguez, José Rivera-Chávez, Robert M. Samples, Cody E. Earp, Huzefa A. Raja, Cedric J. Pearce, Madeleine Ernst, Justin J. J. van der Hooft, Madison E. Adams, Nicholas H. Oberlies, Pieter C. Dorrestein, Jonathan L. Klassen, and Marcy J. Balunas Proceedings of the National Academy of Sciences, 2023, 120, e2219373120. PMID: 37319116; PMCID: PMC10288546; doi: 10.1073/pnas.2219373120 | ![]() |
| 258 | “Evaluating the Antioxidant Properties of the Ancient-Crop Tef (Eragrostis tef) Grain Extracts in THP-1 Monocytes.” Christopher J. Cotter, Allison J. Wright, Anastasia V. Romanov, Tyler N. Graf, Eric D. Whisnant, Laura Flores-Bocanegra, Megan S. Doldron, Nicholas H. Oberlies, Zhenquan Jia, and Ayalew Ligaba-Osena Antioxidants, 2023, 12, 1561 PMID: 37627557; PMCID: PMC10451390; doi: 10.3390/antiox12081561 | ![]() |
| 257 | “Probing the Cytotoxic Signaling Induced by Eupenifeldin in Ovarian Cancer Models.” Amanda C. Maldonado, Monica A. Haughan, Manead Khin, Julia Ekiert, Ziwei Zhang, Daniel Lantvit, Zeinab Y. Al Subeh, Herma C. Pierre, Maryna Salkovski, Tal Hirschhorn, Yu Gao, Cedric J. Pearce, Brent R. Stockwell, Leslie N. Aldrich, Nicholas H. Oberlies, and Joanna E. Burdette Journal of Natural Products, 2023, 86, 2102-2110. PMID: 37643353; PMCID: PMC10792992; doi: 10.1021/acs.jnatprod.3c00186 | ![]() |
| 256 | “In Vitro Evaluation of Neosetophomone B Inducing Apoptosis in Cutaneous T Cell Lymphoma by Targeting the FOXM1 Signaling Pathway.” Shilpa Kuttikrishnan, Tariq Masoodi, Fareed Ahmad, Gulab Sher, Kirti S. Prabhu, Jericha M. Mateo, Joerg Buddenkotte, Tamam El-Elimat, Nicholas H. Oberlies, Cedric J. Pearce, Ajaz A. Bhat, Feras Q. Alali, Martin Steinhoff, and Shahab Uddin Journal of Dermatological Science, 2023, 112, 83-91. PMID: 37865581; doi: 10.1016/j.jdermsci.2023.10.001 | ![]() |
| 255 | “Neosetophomone B Induces Apoptosis in Multiple Myeloma Cells Via Targeting of AKT/SKP2 Signaling Pathway.” Shilpa Kuttikrishnan, Fareed Ahmad, Jericha M. Mateo, Kirti S. Prabhu, Tamam El-Elimat, Nicholas H. Oberlies, Cedric J. Pearce, Ammira S. Alshabeeb Akil, Ajaz A. Bhat, Feras Q. Alali, and Shahab Uddin Cell Biology International, 2024, 48, 190-200. PMID: 37885161; doi: 10.1002/cbin.12101 | ![]() |
| 254 | “What Was Old Is New Again: Phenotypic Screening of a Unique Fungal Library Yields Pyridoxatin, a Promising Lead against Extensively Resistant Acinetobacter Baumannii (Ab5075).” Heather L. Winter, Laura Flores-Bocanegra, Kristóf B. Cank, William J. Crandall, Fridah C. Rotich, Madeline N. Tillman, Daniel A. Todd, Tyler N. Graf, Huzefa A. Raja, Cedric J. Pearce, Nicholas H. Oberlies, and Nadja B. Cech Phytochemistry Letters, 2023, 55, 88-96. PMID: 37252254; PMCID: PMC10210987; doi: 10.1016/j.phytol.2023.04.002 | ![]() |
| 253 | “Translating Kratom-Drug Interactions: From Bedside to Bench and Back.” Rakshit S. Tanna, Nadja B. Cech, Nicholas H. Oberlies, Allan E. Rettie, Kenneth E. Thummel, and Mary F. Paine Drug Metabolism and Disposition, 2023, 51, 923. PMID: 37286363; PMCID: PMC10353077; doi: 10.1124/dmd.122.001005 | ![]() |
| 252 | “Sheptide A: An Antimalarial Cyclic Pentapeptide from a Fungal Strain in the Herpotrichiellaceae.” Robert A. Shepherd, Cody E. Earp, Kristof B. Cank, Huzefa A. Raja, Joanna Burdette, Steven P. Maher, Adriana A. Marin, Anthony A. Ruberto, Sarah Lee Mai, Blaise A. Darveaux, Dennis E. Kyle, Cedric J. Pearce, and Nicholas H. Oberlies The Journal of Antibiotics, 2023, 76, 642-649. PMID: 37731043; PMCID: PMC10602849; doi: 10.1038/s41429-023-00655-6 | ![]() |
| 251 | “Goldenseal-Mediated Inhibition of Intestinal Uptake Transporters Decreases Metformin Systemic Exposure in Mice.” Victoria O. Oyanna, Kenisha Y. Garcia-Torres, Baron J. Bechtold, Katherine D. Lynch, Call M. Ridge, Miklós Horváth, Preston K. Manwill, Tyler N. Graf, Nadja B. Cech, Nicholas H. Oberlies, Mary F. Paine, and John D. Clarke Drug Metabolism and Disposition, 2023, 51, 1483. PMID: 37562957; PMCID: PMC10586506; doi: 10.1124/dmd.123.001360 | ![]() |
| 250 | “Correlative Metabologenomics of 110 Fungi Reveals Metabolite–Gene Cluster Pairs.” Lindsay K. Caesar, Fatma A. Butun, Matthew T. Robey, Navid J. Ayon, Raveena Gupta, David Dainko, Jin Woo Bok, Grant Nickles, Robert J. Stankey, Don Johnson, David Mead, Kristof B. Cank, Cody E. Earp, Huzefa A. Raja, Nicholas H. Oberlies, Nancy P. Keller, and Neil L. Kelleher Nature Chemical Biology, 2023, 19, 846-854. PMID: 36879060; PMCID: PMC10313767; doi: 10.1038/s41589-023-01276-8 | ![]() |
| 249 | “Embellicines C-E: Macrocyclic Alkaloids with a Cyclopenta[b]fluorene Ring System from the Fungus Sarocladium sp.” Zeinab Y. Al Subeh, Laura Flores-Bocanegra, Huzefa A. Raja, Joanna E. Burdette, Cedric J. Pearce, and Nicholas H. Oberlies Journal of Natural Products, 2023, 86, 596-603. PMID: 36884371; PMCID: PMC10043936; doi: 10.1021/acs.jnatprod.2c01048 | ![]() |
| 248 | “From Plant to Cancer Drug: Lessons Learned from the Discovery of Taxol.” Nadja B. Cech, and Nicholas H. Oberlies Natural Product Reports, 2023, 40, 1153-1157. PMID: 37449327; PMCID: PMC10354831; doi: 10.1039/d3np00017f | ![]() |
2022
| 247 | “Editorial for the Special Issue Dedicated to Prof. A. Douglas Kinghorn.” Nicholas H. Oberlies and Mario Figueroa Planta Med, 2022, 88, 696-697. PMID: 35915888; doi: 10.1055/a-1882-1011 | ![]() |
| 246 | “Homoisoflavonoids from the Bulbs of Bellevalia longipes and an Assessment of Their Potential Cytotoxic Activity.” Tamam El-Elimat, Reema Al-Qiam, Joanna E. Burdette, Ahmed H. Al Sharie, Mohammad Al-Gharaibeh, and Nicholas H. Oberlies Phytochemistry, 2022, 203, 113343. PMID: 35963294; PMCID: PMC9795560; doi: 10.1016/j.phytochem.2022.113343 | ![]() |
| 245 | “Lipid Nanoparticle Delivery of Fas Plasmid Restores Fas Expression to Suppress Melanoma Growth in Vivo.” Zeinab Y. Al Subeh, Dakota B. Poschel, Priscilla S. Redd, John D. Klement, Alyssa D. Merting, Dafeng Yang, Megh Mehta, Huidong Shi, Yolonda L. Colson, Nicholas H. Oberlies, Cedric J. Pearce, Aaron H. Colby, Mark W. Grinstaff, and Kebin Liu ACS Nano, 2022, 16, 12695-12710. PMID: 35939651; PMCID: PMC9721370; doi: 10.1021/acsnano.2c04420 | ![]() |
| 244 | “H3K9ME3 Represses G6PD Expression to Suppress the Pentose Phosphate Pathway and ROS Production to Promote Human Mesothelioma Growth.” Chunwan Lu, Dafeng Yang, John D. Klement, Yolonda L. Colson, Nicholas H. Oberlies, Cedric J. Pearce, Aaron H. Colby, Mark W. Grinstaff, Zhuoqi Liu, Huidong Shi, Han-Fei Ding, and Kebin Liu Oncogene, 2022, 41, 2651-2662. PMID: 35351997; PMCID: PMC9058223; doi: 10.1038/s41388-022-02283-0 | ![]() |
| 243 | “Discovery of Anticancer Agents of Diverse Natural Origin.” Leslie N. Aldrich, Joanna E. Burdette, Esperanza Carcache de Blanco, Christopher C. Coss, Alessandra S. Eustaquio, James R. Fuchs, A. Douglas Kinghorn, Amanda MacFarlane, Brittney K. Mize, Nicholas H. Oberlies, Jimmy Orjala, Cedric J. Pearce, Mitch A. Phelps, Liva Harinantenaina Rakotondraibe, Yulin Ren, Djaja Doel Soejarto, Brent R. Stockwell, Jack C. Yalowich, and Xiaoli Zhang Journal of Natural Products, 2022, 85, 702-719. PMID: 35213158; PMCID: PMC9034850; doi: 10.1021/acs.jnatprod.2c00036 | ![]() |
| 242 | “Semisynthesis of Hypothemycin Analogues Targeting the C8–C9 Diol.” Zeinab Y. Al Subeh, Tian Li, Abraham Ustoyev, Jennifer C. Obike, Philip M. West, Manead Khin, Joanna E. Burdette, Cedric J. Pearce, Nicholas H. Oberlies, and Mitchell P. Croatt Journal of Natural Products, 2022, 85, 2018-2025. PMID: 35834411; PMCID: PMC9677340; doi: 10.1021/acs.jnatprod.2c00434 | ![]() |
| 241 | “Genomic and Phenotypic Trait Variation of the Opportunistic Human Pathogen Aspergillus flavus and Its Close Relatives.” E. Anne Hatmaker, Manuel Rangel-Grimaldo, Huzefa A. Raja, Hadi Pourhadi, Sonja L. Knowles, Kevin Fuller, Emily M. Adams, Jorge D. Lightfoot, Rafael W. Bastos, Gustavo H. Goldman, Nicholas H. Oberlies, and Antonis Rokas Microbiology Spectrum, 2022, 10, e03069-03022. PMID: 36318036; PMCID: PMC9769809; doi: 10.1128/spectrum.03069-22 | ![]() |
| 240 | “Bioinformatics Analysis Reveals FOXM1/BUB1B Signaling Pathway as a Key Target of Neosetophomone B in Human Leukemic Cells: A Gene Network-Based Microarray Analysis.” Shilpa Kuttikrishnan, Tariq Masoodi, Gulab Sher, Ajaz A. Bhat, Kalyani Patil, Tamam El-Elimat, Nicholas H. Oberlies, Cedric J. Pearce, Mohmmad Haris, Aamir Ahmad, Feras Q. Alali, and Shahab Uddin Frontiers in Oncology, 2022, 12, PMID: 35847923; PMCID: PMC9283897; doi: 10.3389/fonc.2022.929996 | ![]() |
| 239 | “Anticancer Activity of Neosetophomone B by Targeting AKT/SKP2/MTH1 Axis in Leukemic Cells.” Shilpa Kuttikrishnan, Ajaz A. Bhat, Jericha M. Mateo, Fareed Ahmad, Feras Q. Alali, Tamam El-Elimat, Nicholas H. Oberlies, Cedric J. Pearce, and Shahab Uddin Biochemical and Biophysical Research Communications, 2022, 601, 59-64. PMID: 35228122; doi: 10.1016/j.bbrc.2022.02.071 | ![]() |
| 238 | “Clinical Pharmacokinetic Assessment of Kratom (Mitragyna speciosa), a Botanical Product with Opioid-Like Effects, in Healthy Adult Participants.” Rakshit S. Tanna, James T. Nguyen, Deena L. Hadi, Preston K. Manwill, Laura Flores-Bocanegra, Matthew E. Layton, John R. White, Nadja B. Cech, Nicholas H. Oberlies, Allan E. Rettie, Kenneth E. Thummel, and Mary F. Paine Pharmaceutics, 2022, 14, 620. PMID: 35335999; PMCID: PMC8950611; doi: 10.3390/pharmaceutics14030620 | ![]() |
| 237 | “Metabolomics-Guided Comparison of Pollen and Microalgae-Based Artificial Diets in Honey Bees.” Vincent A. Ricigliano, Kristof B. Cank, Daniel A. Todd, Sonja L. Knowles, and Nicholas H. Oberlies Journal of Agricultural and Food Chemistry, 2022, 70, 9790-9801. PMID: 35881882; PMCID: PMC9372997; doi: 10.1021/acs.jafc.2c02583 | ![]() |
| 236 | “Genomic Characterization of Parengyodontium Torokii sp. nov., a Biofilm-Forming Fungus Isolated from Mars 2020 Assembly Facility.” Ceth W. Parker, Marcus D. Teixeira, Nitin K. Singh, Huzefa A. Raja, Kristof B. Cank, Giada Spigolon, Nicholas H. Oberlies, Bridget M. Barker, Jason E. Stajich, Christopher E. Mason, and Kasthuri Venkateswaran Journal of Fungi, 2022, 8, 66. PMID: 35050006; PMCID: PMC8778116; doi: 10.3390/jof8010066 | ![]() |
| 235 | “Kratom (Mitragyna speciosa) Validation: Quantitative Analysis of Indole and Oxindole Alkaloids Reveals Chemotypes of Plants and Products.” Preston K. Manwill, Laura Flores-Bocanegra, Manead Khin, Huzefa A. Raja, Nadja B. Cech, Nicholas H. Oberlies, and Daniel A. Todd Planta Medica, 2022, 88, 838-857. PMID: 35468648; PMCID: PMC9343938; doi: 10.1055/a-1795-5876 | ![]() |
| 234 | “G6PD Functions as a Metabolic Checkpoint to Regulate Granzyme B Expression in Tumor-Specific Cytotoxic T Lymphocytes.” Chunwan Lu, Dafeng Yang, John D. Klement, Yolonda L. Colson, Nicholas H. Oberlies, Cedric J. Pearce, Aaron H. Colby, Mark W. Grinstaff, Han-Fei Ding, Huidong Shi, and Kebin Liu Journal for ImmunoTherapy of Cancer, 2022, 10, e003543. PMID: 35017152; PMCID: PMC8753452; doi: 10.1136/jitc-2021-003543 | ![]() |
| 233 | “Natural Resorcylic Acid Lactones: A Chemical Biology Approach for Anticancer Activity.” Shilpa Kuttikrishnan, Kirti S. Prabhu, Ahmed H. Al Sharie, Yazan O. Al Zu’bi, Feras Q. Alali, Nicholas H. Oberlies, Aamir Ahmad, Tamam El-Elimat, and Shahab Uddin Drug Discovery Today, 2022, 27, 547-557. PMID: 34655796; doi: 10.1016/j.drudis.2021.10.001 | ![]() |
| 232 | “Fungal–Fungal Co-Culture: A Primer for Generating Chemical Diversity.” Sonja L. Knowles, Huzefa A. Raja, Christopher D. Roberts, and Nicholas H. Oberlies Natural Product Reports, 2022, 39, 1557-1573. PMID: 35137758; PMCID: PMC9384855; doi: 10.1039/d1np00070e | ![]() |
| 231 | “Dereplication of Fungal Metabolites by Nmr-Based Compound Networking Using MADByTE.” Laura Flores-Bocanegra, Zeinab Y. Al Subeh, Joseph M. Egan, Tamam El-Elimat, Huzefa A. Raja, Joanna E. Burdette, Cedric J. Pearce, Roger G. Linington, and Nicholas H. Oberlies Journal of Natural Products, 2022, 85, 614-624. PMID: 35020372; PMCID: PMC8957573; doi: 10.1021/acs.jnatprod.1c00841 | ![]() |
| 230 | “Regulation of Gliotoxin Biosynthesis and Protection in Aspergillus Species.” Patrícia Alves de Castro, Ana Cristina Colabardini, Maísa Moraes, Maria Augusta Crivelente Horta, Sonja L. Knowles, Huzefa A. Raja, Nicholas H. Oberlies, Yasuji Koyama, Masahiro Ogawa, Katsuya Gomi, Jacob L. Steenwyk, Antonis Rokas, Relber A. Gonçales, Cláudio Duarte-Oliveira, Agostinho Carvalho, Laure N. A. Ries, and Gustavo H. Goldman PLOS Genetics, 2022, 18, e1009965. PMID: 35041649; PMCID: PMC8797188; doi: 10.1371/journal.pgen.1009965 | ![]() |
| 229 | “Polychlorinated Cyclopentenes from a Marine Derived Periconia sp. (Strain G1144).” Kristóf B. Cank, Robert A. Shepherd, Sonja L. Knowles, Manuel Rangel-Grimaldo, Huzefa A. Raja, Zoie L. Bunch, Nadja B. Cech, Christopher A. Rice, Dennis E. Kyle, Joseph O. Falkinham, Joanna E. Burdette, and Nicholas H. Oberlies Phytochemistry, 2022, 199, 113200. PMID: 35421431; PMCID: PMC9173697; doi: 10.1016/j.phytochem.2022.113200 | ![]() |
| 228 | “Structural Diversity of Perylenequinones Is Driven by Their Redox Behavior.” Zeinab Y. Al Subeh, Amy L. Waldbusser, Huzefa A. Raja, Cedric J. Pearce, Kin Lok Ho, Michael J. Hall, Michael R. Probert, Nicholas H. Oberlies, and Shabnam Hematian The Journal of Organic Chemistry, 2022, 87, 2697-2710. PMID: 35077640; PMCID: PMC8898278; doi: 10.1021/acs.joc.1c02639 | ![]() |
2021
| 227 | “Cytotoxic and Antimicrobial Drimane Meroterpenoids from a Fungus of the Stictidaceae (Ostropales, Ascomycota).” Laura Flores-Bocanegra, Mario Augustinović, Huzefa A. Raja, Steven J. Kurina, Amanda C. Maldonado, Joanna E. Burdette, Joseph O. Falkinham, Cedric J. Pearce, and Nicholas H. Oberlies Tetrahedron Letters, 2021, 68, 152896. PMID: 35431352; PMCID: PMC9012486; doi: 10.1016/j.tetlet.2021.152896 | ![]() |
| 226 | “Genomic and Phenotypic Analysis of COVID-19-Associated Pulmonary Aspergillosis Isolates of Aspergillus fumigatus.” L. Steenwyk Jacob, E. Mead Matthew, Alves de Castro Patrícia, Clara Valero, André Damasio, A. C. dos Santos Renato, L. Labella Abigail, Yuanning Li, L. Knowles Sonja, A. Raja Huzefa, H. Oberlies Nicholas, Xiaofan Zhou, A. Cornely Oliver, Frieder Fuchs, Philipp Koehler, H. Goldman Gustavo, Antonis Rokas, and A. Cuomo Christina Microbiology Spectrum, 9, e00010-00021. PMID: 34106569; PMCID: PMC8552514; doi: 10.1128/Spectrum.00010-21 | ![]() |
| 225 | “Occasional Comment: Fungal Identification to Species-Level Can Be Challenging.” Huzefa A. Raja, Nicholas H. Oberlies, and Marc Stadler Phytochemistry, 2021, 190, 112855. PMID: 34273757; doi: 10.1016/j.phytochem.2021.112855 | |
| 224 | “Hepatic Organic Anion Transporting Polypeptides Mediate Disposition of Milk Thistle Flavonolignans and Pharmacokinetic Silymarin-Drug Interactions.” Katherine D. Lynch, Michelle L. Montonye, Dan-Dan Tian, Tarana Arman, Victoria O. Oyanna, Baron J. Bechtold, Tyler N. Graf, Nicholas H. Oberlies, Mary F. Paine, and John D. Clarke Phytotherapy Research, 2021, 35, 3286-3297. PMID: 33587330; PMCID: PMC8217340; doi: 10.1002/ptr.7049 | |
| 223 | “Polyphasic Approach Utilized for the Identification of Two New Toxigenic Members of Penicillium Section Exilicaulis, P. krskae and P. silybi spp. Nov.” Roman Labuda, Markus Bacher, Thomas Rosenau, Erika Gasparotto, Hannes Gratzl, Maria Doppler, Michael Sulyok, Alena Kubátová, Harald Berger, Kristof Cank, Huzefa A. Raja, Nicholas H. Oberlies, Christoph Schüller, and Joseph Strauss Journal of Fungi, 2021, 7, 557. PMID: 34356936; PMCID: PMC8307998; doi: 10.3390/jof7070557 | ![]() |
| 222 | “Freshwater Fungi as a Source of Chemical Diversity: A Review.” Tamam El-Elimat, Huzefa A. Raja, Mario Figueroa, Ahmed H. Al Sharie, Rick L. Bunch, and Nicholas H. Oberlies Journal of Natural Products, 2021, 84, 898-916. PMID: 33662206; PMCID: PMC8127292; doi: 10.1021/acs.jnatprod.0c01340 | ![]() |
| 221 | “Coumarins, Dihydroisocoumarins, a Dibenzo-α-Pyrone, a Meroterpenoid, and a Merodrimane from Talaromyces amestolkiae.” Tamam El-Elimat, Mario Figueroa, Huzefa A. Raja, Soraya Alnabulsi, and Nicholas H. Oberlies Tetrahedron Letters, 2021, 72, 153067. PMID: 34421136; PMCID: PMC8378670; doi: 10.1016/j.tetlet.2021.153067 | ![]() |
| 220 | “Pilot-Scale Production of Expansile Nanoparticles: Practical Methods for Clinical Scale-Up.” Aaron H. Colby, Rong Liu, Robert P. Doyle, Alyssa Merting, Heng Zhang, Natasha Savage, Ngoc-Quynh Chu, Beth A. Hollister, William McCulloch, Joanna E. Burdette, Cedric J. Pearce, Kebin Liu, Nicholas H. Oberlies, Yolonda L. Colson, and Mark W. Grinstaff Journal of Controlled Release, 2021, 337, 144-154. PMID: 34280414; PMCID: PMC8489532; doi: 10.1016/j.jconrel.2021.07.012 | |
| 219 | “Droplet Probe: A Non-Destructive Residue Analysis of Wari Ceramics from the Imperial Heartland.” Kristóf B. Cank, Joshua M. Henkin, Anita G. Cook, and Nicholas H. Oberlies Journal of Archaeological Science, 2021, 134, 105468. doi: 10.1016/j.jas.2021.105468 | ![]() |
| 218 | “Media and Strain Studies for the Scaled Production of Cis-Enone Resorcylic Acid Lactones as Feedstocks for Semisynthesis.” Zeinab Y. Al Subeh, Huzefa A. Raja, Jennifer C. Obike, Cedric J. Pearce, Mitchell P. Croatt, and Nicholas H. Oberlies The Journal of Antibiotics, 2021, 74, 496-507. PMID: 34155352; PMCID: PMC8313427; doi: 10.1038/s41429-021-00432-3 | ![]() |
| 217 | “Three Diketomorpholines from a Penicillium sp. (Strain G1071).” Zeinab Y. Al Subeh, Huzefa A. Raja, Joanna E. Burdette, Joseph O. Falkinham, Scott E. Hemby, and Nicholas H. Oberlies Phytochemistry, 2021, 189, 112830 PMID: 34157637; PMCID: PMC8292221; doi: 10.1016/j.phytochem.2021.112830 | ![]() |
| 216 | “Semisynthetic Derivatives of the Verticillin Class of Natural Products through Acylation of the C11 Hydroxy Group.” Chiraz Soumia M. Amrine, Andrew C. Huntsman, Michael G. Doyle, Joanna E. Burdette, Cedric J. Pearce, James R. Fuchs, and Nicholas H. Oberlies ACS Medicinal Chemistry Letters, 2021, 12, 625-630. PMID: 33859802; PMCID: PMC8040035; doi: 10.1021/acsmedchemlett.1c00024 | ![]() |
| 215 | “Opportunities and Limitations for Assigning Relative Configurations of Antibacterial Bislactones Using GIAO NMR Shift Calculations.” Sonja L. Knowles, Christopher D. Roberts, Mario Augustinović, Laura Flores-Bocanegra, Huzefa A. Raja, Kimberly N. Heath-Borrero, Joanna E. Burdette, Joseph O. Falkinham III, Cedric J. Pearce, and Nicholas H. Oberlies Journal of Natural Products, 2021, 84, 1254-1260. PMID: 33764773; PMCID: PMC8108483; doi: 10.1021/acs.jnatprod.0c01309 | ![]() |
| 214 | “Thielavins: Tuned Biosynthesis and LR-HSQMBC for Structure Elucidation.” Zeinab Y. Al Subeh, Huzefa A. Raja, Amanda Maldonado, Joanna E. Burdette, Cedric J. Pearce, and Nicholas H. Oberlies The Journal of Antibiotics, 2021, 74, 300-306. PMID: 33495550; PMCID: PMC8084880; doi: 10.1038/s41429-021-00405-6 | ![]() |
| 213 | “Delivery of Eupenifeldin via Polymer-Coated Surgical Buttresses Prevents Local Lung Cancer Recurrence.” Zeinab Y. Al Subeh, Ngoc-Quynh Chu, Jeremy T. Korunes-Miller, Lillian L. Tsai, Tyler N. Graf, Yin P. Hung, Cedric J. Pearce, Mark W. Grinstaff, Aaron H. Colby, Yolonda L. Colson, and Nicholas H. Oberlies Journal of Controlled Release, 2021, 331, 260-269. PMID: 33484778; PMCID: PMC7946725; doi: 10.1016/j.jconrel.2021.01.026 | ![]() |
| 212 | “Refined Prediction of Pharmacokinetic Kratom-Drug Interactions: Time-Dependent Inhibition Considerations.” Rakshit S. Tanna, Dan-Dan Tian, Nadja B. Cech, Nicholas H. Oberlies, Allan E. Rettie, Kenneth E. Thummel, and Mary F. Paine Journal of Pharmacology and Experimental Therapeutics, 2021, 376, 64-73. PMID: 33093187; PMCID: PMC7745086; doi: 10.1124/jpet.120.000270 | ![]() |
| 211 | “Capturing the Antimicrobial Profile of Rosmarinus officinalis against Methicillin-Resistant Staphylococcus aureus (MRSA) with Bioassay-Guided Fractionation and Bioinformatics.” Manead Khin, Sonja L. Knowles, William J. Crandall, Derick D. Jones, Nicholas H. Oberlies, Nadja B. Cech, and Joëlle Houriet Journal of Pharmaceutical and Biomedical Analysis, 2021, 197, 113965. PMID: 33640687; PMCID: PMC8191859; doi: 10.1016/j.jpba.2021.113965 | ![]() |
| 210 | “Cytotoxic Naphthoquinone Analogues, Including Heterodimers, and Their Structure Elucidation Using LR-HSQMBC NMR Experiments.” Laura Flores-Bocanegra, Huzefa A. Raja, Jeffrey W. Bacon, Amanda C. Maldonado, Joanna E. Burdette, Cedric J. Pearce, and Nicholas H. Oberlies Journal of Natural Products, 2021, 84, 771-778 PMID: 33006889; PMCID: PMC8005429; doi: 10.1021/acs.jnatprod.0c00856 | ![]() |
2020
| 209 | “Variation among Biosynthetic Gene Clusters, Secondary Metabolite Profiles, and Cards of Virulence across Aspergillus Species.” Jacob L. Steenwyk, Matthew E. Mead, Sonja L. Knowles, Huzefa A. Raja, Christopher D. Roberts, Oliver Bader, Jos Houbraken, Gustavo H. Goldman, Nicholas H. Oberlies, and Antonis Rokas Genetics, 2020, 216, 481. PMID: 32817009; PMCID: PMC7536862; doi: 10.1534/genetics.120.303549 | ![]() |
| 208 | “Bioactive Diterpenoid Metabolism and Cytotoxic Activities of Genetically Transformed Euphorbia Lathyris Roots.” Vincent A. Ricigliano, Vincent P. Sica, Sonja L. Knowles, Nicole Diette, Dianella G. Howarth, and Nicholas H. Oberlies Phytochemistry, 2020, 179, 112504. PMID: 32980713; PMCID: PMC7863580; doi: 10.1016/j.phytochem.2020.112504 | ![]() |
| 207 | “Phenethyisoquinoline Alkaloids from the Leaves of Androcymbium palaestinum.” Tamam El-Elimat, Maram B. Alhawarri, José Rivera-Chávez, Joanna E. Burdette, Austin Czarnecki, Mohammad Al-Gharaibeh, Ahmed H. Al Sharie, Ahmed Alhusban, Feras Q. Alali, and Nicholas H. Oberlies Fitoterapia, 2020, 146, 104706. PMID: 32829012; PMCID: PMC7871506; doi: 10.1016/j.fitote.2020.104706 | ![]() |
| 206 | “Enhanced Production and Anticancer Properties of Photoactivated Perylenequinones.” Zeinab Y. Al Subeh, Huzefa A. Raja, Susan Monro, Laura Flores-Bocanegra, Tamam El-Elimat, Cedric J. Pearce, Sherri A. McFarland, and Nicholas H. Oberlies Journal of Natural Products, 2020, 83, 2490-2500. PMID: 32786877; PMCID: PMC7493285; doi: 10.1021/acs.jnatprod.0c00492 Erratum in Correction to Enhanced Production and Anticancer Properties of Photoactivated Perylenequinones [Journal of Natural Products, 2020, 83, 3765-3766]. PMID: 33314937; doi: 10.1021/acs.jnatprod.0c01289 | ![]() |
| 205 | “Chemical Composition and Biological Effects of Kratom (Mitragyna Speciosa): In Vitro Studies with Implications for Efficacy and Drug Interactions” Daniel A. Todd, Joshua J. Kellogg, E. Diane Wallace, Manead Khin, Laura Flores-Bocanegra, Rakshit S. Tanna, Scot McIntosh, Huzefa A. Raja, Tyler N. Graf, Scott E. Hemby, Mary F. Paine, Nicholas H. Oberlies, and Nadja B. Cech Scientific Reports, 2020, 10, 19158. PMID: 33154449; PMCID: PMC7645423; doi: 10.1038/s41598-020-76119-w | |
| 204 | “The Chemistry of Kratom [Mitragyna speciosa]: Updated Characterization Data and Methods to Elucidate Indole and Oxindole Alkaloids” Laura Flores-Bocanegra, Huzefa A. Raja, Tyler N. Graf, Mario Augustinović, E. Diane Wallace, Shabnam Hematian, Joshua J. Kellogg, Daniel A. Todd, Nadja B. Cech, and Nicholas H. Oberlies Journal of Natural Products, 2020, 83(7), 2165-2177. PMID: 32597657; PMCID: PMC7718854; doi: 10.1021/acs.jnatprod.0c00257 | ![]() |
| 203 | “Pathogenic Allodiploid Hybrids of Aspergillus Fungi” Jacob L. Steenwyk, Abigail L. Lind, Laure N. A. Ries, Thaila F. Dos Reis, Lilian P. Silva, Fausto Almeida, Rafael W. Bastos, Thais Fernanda de Campos Fraga da Silva, Vania L. D. Bonato, André Moreira Pessoni, Fernando Rodrigues, Huzefa A. Raja, Sonja L. Knowles, Nicholas H. Oberlies, Katrien Lagrou, Gustavo H. Goldman, and Antonis Rokas Current Biology, 2020, 30(13), 2495-2507.e7. PMID: 32502407, PMCID: PMC7343619, doi: 10.1016/j.cub.2020.04.071 | ![]() |
| 202 | “Biosynthetic Gene Clusters and the Evolution of Fungal Chemodiversity” Antonis Rokas, Matthew E. Mead, Jacob L. Steenwyk, Huzefa A. Raja, and Nicholas H. Oberlies Natural Product Reports, 2020, 37(7), 868-878. PMID: 31898704, PMCID: PMC7332410, doi: 10.1039/c9np00045c | ![]() |
| 201 | “Drug Leads from Endophytic Fungi: Lessons Learned via Scaled Production” Tyler N. Graf, Diana Kao, José Rivera-Chávez, Jacklyn M. Gallagher, Huzefa A. Raja, and Nicholas H. Oberlies Planta Medica, 2020, 86, 988-996. PMID: 32219776; PMCID: PMC7511429; doi: 10.1055/a-1130-4856 | ![]() |
| 200 | “Wheldone: Characterization of a Unique Scaffold from the Coculture of Aspergillus fischeri and Xylaria flabelliformis.” Sonja L. Knowles, Huzefa A. Raja, Israa H. Isawi, Laura Flores-Bocanegra, Patricia H. Reggio, Cedric J. Pearce, Joanna E. Burdette, Antonis Rokas, and Nicholas H. Oberlies Organic Letters, 2020, 22, 1878-1882. PMID: 32096649; PMCID: PMC7153779; doi: 10.1021/acs.orglett.0c00219 | ![]() |
| 199 | “Evolving Moldy Murderers: Aspergillus Section Fumigati as a Model for Studying the Repeated Evolution of Fungal Pathogenicity.” Antonis Rokas, Matthew E. Mead, Jacob L. Steenwyk, Nicholas H. Oberlies, and Gustavo H. Goldman PLOS Pathogens, 2020, 16, e1008315. PMID: 32106242; PMCID: PMC7046185; doi: 10.1371/journal.ppat.1008315 | ![]() |
| 198 | “Gliotoxin, a Known Virulence Factor in the Major Human Pathogen Aspergillus fumigatus, Is Also Biosynthesized by Its Nonpathogenic Relative Aspergillus fischeri.” Sonja L. Knowles, Matthew E. Mead, Lilian Pereira Silva, Huzefa A. Raja, Jacob L. Steenwyk, Gustavo H. Goldman, Nicholas H. Oberlies, and Antonis Rokas mBio, 2020, 11, e03361-03319. PMID: 32047138; PMCID: PMC7018655; doi: 10.1128/mBio.03361-19 | ![]() |
| 197 | “New Tricks for Old Dogs: Two New Macrocyclic Trichothecene Epimers and Absolute Configuration of 16-Hydroxyverrucarin B.” Diana Kao, Laura Flores-Bocanegra, Huzefa A. Raja, Blaise A. Darveaux, Cedric J. Pearce, and Nicholas H. Oberlies Phytochemistry, 2020, 172, 112238. PMID: 31931448; PMCID: PMC7050405; doi: 10.1016/j.phytochem.2019.112238 | ![]() |
| 196 | “Verticillin A Causes Apoptosis and Reduces Tumor Burden in High-Grade Serous Ovarian Cancer by Inducing DNA Damage.” Amrita Salvi, Chiraz Soumia M. Amrine, Julia R. Austin, KiAundra Kilpatrick, Angela Russo, Daniel Lantvit, Esther Calderon-Gierszal, Zachary Mattes, Cedric J. Pearce, Mark W. Grinstaff, Aaron H. Colby, Nicholas H. Oberlies, and Joanna E. Burdette Molecular Cancer Therapeutics, 2020, 19, 89-100. PMID: 31909733; PMCID: PMC6951445; doi: 10.1158/1535-7163.MCT-19-0205 | ![]() |
| 195 | “Syntaxin 6-Mediated Exosome Secretion Regulates Enzalutamide Resistance in Prostate Cancer.” Taylor C. Peak, Gati K. Panigrahi, Prakash P. Praharaj, Yixin Su, Lihong Shi, Jacqueline Chyr, José Rivera-Chávez, Laura Flores-Bocanegra, Ravi Singh, Donald J. Vander Griend, Nicholas H. Oberlies, Bethany A. Kerr, Ashok Hemal, Rhonda L. Bitting, and Gagan Deep Molecular Carcinogenesis, 2020, 59, 62-72. PMID: 31674708; PMCID: PMC6916724; doi: 10.1002/mc.23129 | ![]() |
2019
| 194 | “Droplet Probe: Coupling Chromatography to the In Situ Evaluation of the Chemistry of Nature.” Nicholas H. Oberlies, Sonja L Knowles, Chiraz Soumia M. Amrine, Diana Kao, Vilmos Kertesz, and Huzefa A. Raja Natural Product Reports, 2019, 36, 944-959. PMID: 31112181; PMCID: PMC6640111; doi: 10.1039/c9np00019d | ![]() |
| 193 | “Development of a Consensus Approach for Botanical Safety Evaluation – A Roundtable Report.” Corrado L. Galli, Nigel J. Walker, Nicholas H. Oberlies, Amy L. Roe, James Edwards, Suzanne Fitzpatrick, James C. Griffiths, A. Wallace Hayes, Catherine Mahony, Daniel S. Marsman, and Lara O’Keeffe Toxicology Letters, 2019, 314, 10-17. PMID: 31082523; doi: 10.1016/j.toxlet.2019.05.008 | |
| 192 | “Selection and Characterization of Botanical Natural Products for Research Studies: A NaPDI Center Recommended Approach.” Joshua J. Kellogg, Mary F. Paine, Jeannine S. McCune, Nicholas H. Oberlies, and Nadja B. Cech Natural Product Reports, 2019, 36, 1196-1221. PMID: 30681109; PMCID: PMC6658353; doi: 10.1039/c8np00065d | ![]() |
| 191 | “An Unusual Burkholderia gladioli double Chain-Initiating Nonribosomal Peptide Synthetase Assembles ‘Fungal’ Icosalide Antibiotics.” Matthew Jenner, Xinyun Jian, Yousef Dashti, Joleen Masschelein, Christian Hobson, Douglas M. Roberts, Cerith Jones, Simon Harris, Julian Parkhill, Huzefa A. Raja, Nicholas H. Oberlies, Cedric J. Pearce, Eshwar Mahenthiralingam, and Gregory L. Challis Chemical Science, 2019, 10, 5489-5494. PMID: 31293732; PMCID: PMC6553374; doi: 10.1039/c8sc04897e | ![]() |
| 190 | “Metabolites from the Marine-facultative Aspergillus sp. MEXU 27854 and Gymnoascus hyalinosporus MEXU 29901 from Caleta Bay, Mexico.” Manuel A. Aparicio-Cuevas, María del Carmen González, Huzefa A. Raja, Isabel Rivero-Cruz, Steven J. Kurina, Joanna E. Burdette, Nicholas H. Oberlies, and Mario Figueroa Tetrahedron Letters, 2019, 60, 1649-1652. PMID: 32390667; PMCID: PMC7207482; doi: 10.1016/j.tetlet.2019.05.037 | ![]() |
| 189 | “Pheophorbide Derivatives Isolated From Açaí Berries (Euterpea oleracea) Activate an Antioxidant Response Element In Vitro.” Suneel K. Kandagatla, Robin Tate Uhl, Tyler N. Graf, Nicholas H. Oberlies, and Gregory M. Raner Natural Product Communications, 2019, 14. PMID: 33214801; PMCID: PMC7673296; doi: 10.1177/1934578X19852443 | |
| 188 | “Apicidin Attenuates MRSA Virulence through Quorum-Sensing Inhibition and Enhanced Host Defense.” Corey P. Parlet, Jeffrey S. Kavanaugh, Heidi A. Crosby, Huzefa A. Raja, Tamam El-Elimat, Daniel A. Todd, Cedric J. Pearce, Nadja B. Cech, Nicholas H. Oberlies, and Alexander R. Horswill Cell Reports, 2019, 27, 187-198.e186. PMID: 30943400; PMCID: PMC7224364; doi: 10.1016/j.celrep.2019.03.018 | ![]() |
| 187 | “Greensporone A, a Fungal Secondary Metabolite Suppressed Constitutively Activated AKT via ROS Generation and Induced Apoptosis in Leukemic Cell Lines.” Kirti S. Prabhu, Kodappully S. Siveen, Shilpa Kuttikrishnan, Anh Jochebeth, Tayyiba A. Ali, Noor R. Elareer, Ahmad Iskandarani, Abdul Quaiyoom Khan, Maysaloun Merhi, Said Dermime, Tamam El-Elimat, Nicholas H. Oberlies, Feras Q. Alali, Martin Steinhoff, and Shahab Uddin Biomolecules, 2019, 9, 126. PMID: 30934922; PMCID: PMC6523683; doi: 10.3390/biom9040126 | ![]() |
| 186 | “Prenylated Diresorcinols Inhibit Bacterial Quorum Sensing.” Noemi D. Paguigan, José Rivera-Chávez, Justin J. Stempin, Mario Augustinović, Aleksandra I. Noras, Huzefa A. Raja, Daniel A. Todd, Kathleen D. Triplett, Cynthia Day, Mario Figueroa, Pamela R. Hall, Nadja B. Cech, and Nicholas H. Oberlies Journal of Natural Products, 2019, 82, 550-558. PMID: 30730742; doi: 10.1021/acs.jnatprod.8b00925 | ![]() |
| 185 | “SUV39H1 Represses the Expression of Cytotoxic T-Lymphocyte Effector Genes to Promote Colon Tumor Immune Evasion.” Chunwan Lu, Dafeng Yang, John D. Klement, Il Kyu Oh, Natasha M. Savage, Jennifer L. Waller, Aaron H. Colby, Mark W. Grinstaff, Nicholas H. Oberlies, Cedric J. Pearce, Zhiliang Xie, Samuel K. Kulp, Christopher C. Coss, Mitch A. Phelps, Thomas Albers, Iryna O. Lebedyeva, and Kebin Liu Cancer Immunology Research, 2019, 7, 414. PMID: 30610059; PMCID: PMC6397681; doi: 10.1158/2326-6066.CIR-18-0126 | |
| 184 | “Engineering Fluorine into Verticillins (Epipolythiodioxopiperazine Alkaloids) via Precursor-Directed Biosynthesis.” Chiraz Soumia M. Amrine, Jessica L. Long, Huzefa A. Raja, Steven J. Kurina, Joanna E. Burdette, Cedric J. Pearce, and Nicholas H. Oberlies Journal of Natural Products, 2019, 82, 3104-3110. PMID: 31633350; PMCID: PMC6996222; doi: 10.1021/acs.jnatprod.9b00711 | ![]() |
| 183 | “Orthogonal Method for Double-Bond Placement via Ozone-Induced Dissociation Mass Spectrometry (OzID-MS).” Sonja L. Knowles, Ngoc Vu, Daniel A. Todd, Huzefa A. Raja, Antonis Rokas, Qibin Zhang, and Nicholas H. Oberlies Journal of Natural Products, 2019, 82, 3421-3431. PMID: 31823607; PMCID: PMC7004233; doi: 10.1021/acs.jnatprod.9b00787 | ![]() |
| 182 | “Draft Genome Sequence of the Griseofulvin-Producing Fungus Xylaria flabelliformis Strain G536.” Matthew E. Mead, Huzefa A. Raja, Jacob L. Steenwyk, Sonja L. Knowles, Nicholas H. Oberlies, and Antonis Rokas Microbiology Resource Announcements, 2019, 8, e00890-00819. PMID: 31537670; PMCID: PMC6753274; doi: 10.1128/MRA.00890-19 | ![]() |
| 181 | “Mapping the Fungal Battlefield: Using in situ Chemistry and Deletion Mutants to Monitor Interspecific Chemical Interactions between Fungi.” Sonja L. Knowles, Huzefa A. Raja, Allison J. Wright, Ann Marie L. Lee, Lindsay K. Caesar, Nadja B. Cech, Matthew E. Mead, Jacob L. Steenwyk, Laure N. A. Ries, Gustavo H. Goldman, Antonis Rokas, and Nicholas H. Oberlies Frontiers in Microbiology, 2019, 10, 285. PMID: 30837981; PMCID: PMC6389630; doi: 10.3389/fmicb.2019.00285 | ![]() |
| 180 | “Characterizing the Pathogenic, Genomic, and Chemical Traits of Aspergillus fischeri, a Close Relative of the Major Human Fungal Pathogen Aspergillus fumigatus.” Matthew E. Mead, Sonja L. Knowles, Huzefa A. Raja, Sarah R. Beattie, Caitlin H. Kowalski, Jacob L. Steenwyk, Lilian P. Silva, Jessica Chiaratto, Laure N. A. Ries, Gustavo H. Goldman, Robert A. Cramer, Nicholas H. Oberlies, and Antonis Rokas mSphere, 2018, 4, e00018-00019. PMID: 30787113; PMCID: PMC6382966, doi: 10.1128/mSphere.00018-19 | ![]() |
| 179 | “Meroterpenoids from Neosetophoma Sp.: A Dioxa[4.3.3]Propellane Ring System, Potent Cytotoxicity, and Prolific Expression.” Tamam El-Elimat, Huzefa A. Raja, Sloan Ayers, Steven J. Kurina, Joanna E. Burdette, Zachary Mattes, Robert Sabatelle, Jeffrey W. Bacon, Aaron H. Colby, Mark W. Grinstaff, Cedric J. Pearce, and Nicholas H. Oberlies Organic Letters, 2019, 21, 529-534. PMID: 30620608; PMCID: PMC6343109; doi: 10.1021/acs.orglett.8b03769 | ![]() |
| 178 | “Delitpyrones: α-Pyrone Derivatives from a Freshwater Delitschia Sp.” José Rivera-Chávez, Tamam El-Elimat, Jacklyn M. Gallagher, Tyler N. Graf, Jacques Fournier, Gati K. Panigrahi, Gagan Deep, Rick L. Bunch, Huzefa A. Raja, and Nicholas H. Oberlies Planta Medica, 2019, 85, 62-71. PMID: 30016827; doi: 10.1055/a-0654-5850 | ![]() |
| 177 | “Mycopyranone: A 8,8ˈ-Binaphthopyranone with Potent Anti-Mrsa Activity from the Fungus Phialemoniopsis Sp.” José Rivera-Chávez, Lindsay K. Caesar, Juan J. Garcia-Salazar, Huzefa A. Raja, Nadja B. Cech, Cedric J. Pearce, and Nicholas H. Oberlies Tetrahedron Letters, 2019, 60, 594-597. PMID: 31598014; PMCID: PMC6785197; doi: 10.1016/j.tetlet.2019.01.029 | ![]() |
| 176 | “The Value of Universally Available Raw NMR Data for Transparency, Reproducibility, and Integrity in Natural Product Research.” James B. McAlpine, Shao-Nong Chen, Andrei Kutateladze, John B. MacMillan, Giovanni Appendino, Andersson Barison, Mehdi A. Beniddir, Maique W. Biavatti, Stefan Bluml, Asmaa Boufridi, Mark S. Butler, Robert J. Capon, Young H. Choi, David Coppage, Phillip Crews, Michael T. Crimmins, Marie Csete, Pradeep Dewapriya, Joseph M. Egan, Mary J. Garson, Grégory Genta-Jouve, William H. Gerwick, Harald Gross, Mary Kay Harper, Precilia Hermanto, James M. Hook, Luke Hunter, Damien Jeannerat, Nai-Yun Ji, Tyler A. Johnson, David G. I. Kingston, Hiroyuki Koshino, Hsiau-Wei Lee, Guy Lewin, Jie Li, Roger G. Linington, Miaomiao Liu, Kerry L. McPhail, Tadeusz F. Molinski, Bradley S. Moore, Joo-Won Nam, Ram P. Neupane, Matthias Niemitz, Jean-Marc Nuzillard, Nicholas H. Oberlies, Fernanda M. M. Ocampos, Guohui Pan, Ronald J. Quinn, D. Sai Reddy, Jean-Hugues Renault, José Rivera-Chávez, Wolfgang Robien, Carla M. Saunders, Thomas J. Schmidt, Christoph Seger, Ben Shen, Christoph Steinbeck, Hermann Stuppner, Sonja Sturm, Orazio Taglialatela-Scafati, Dean J. Tantillo, Robert Verpoorte, Bin-Gui Wang, Craig M. Williams, Philip G. Williams, Julien Wist, Jian-Min Yue, Chen Zhang, Zhengren Xu, Charlotte Simmler, David C. Lankin, Jonathan Bisson, and Guido F. Pauli Natural Product Reports, 2019, 36, 35-107. PMID: 30003207; PMCID: PMC6350634; doi: 10.1039/c7np00064b Erratum in Correction: The value of universally available raw NMR data for transparency, reproducibility, and integrity in natural product research. [Natural Product Reports, 2019, 36, 35-107] | ![]() |
| 175 | “Silymarin Prevents Memory Impairments, Anxiety, and Depressive-Like Symptoms in a Rat Model of Post-Traumatic Stress Disorder.” Tamam El-Elimat, Karem H. Alzoubi, Mahmoud M. AbuAlSamen, Zeinab Y. Al Subeh, Tyler N. Graf, and Nicholas H. Oberlies Planta Medica, 2019, 85, 32-40. PMID: 30153692; doi: 10.1055/a-0710-5673 | ![]() |
2018
| 174 | “Non-Destructive Chemical Analysis of a Garcinia mangostana L. (Mangosteen) Herbarium Voucher Specimen.” Diana Kao, Joshua M.Henkin, Djaja Djendoel Soejarto, A. Douglas Kinghorn, and Nicholas H.Oberlies Phytochemistry Letters, 2018, 28, 124-129. PMID: 30613309; PMCID: PMC6317376; doi: 10.1016/j.phytol.2018.10.001 |
| 173 | “Media Studies to Enhance the Production of Verticillins Facilitated by in Situ Chemical Analysis.” Chiraz Soumia M. Amrine, Huzefa A. Raja, Blaise A. Darveaux, Cedric J. Pearce, and Nicholas H. Oberlies Journal of Industrial Microbiology & Biotechnology, 2018, 45, 1053-1065. PMID: 30259213; PMCID: PMC6251749; doi: 10.1007/s10295-018-2083-8 |
| 172 | “Development and Utilization of a Palladium-Catalyzed Dehydration of Primary Amides to Form Nitriles.” Mohammed H. Al-Huniti, José Rivera-Chávez, Katsuya L. Colón, Jarrod L. Stanley, Joanna E. Burdette, Cedric J. Pearce, Nicholas H. Oberlies, and Mitchell P. Croatt Organic Letters, 2018, 20, 6046-6050. PMID: 30221526; PMCID: PMC6179452; doi: 10.1021/acs.orglett.8b02422 |
| 171 | “Calothrixamides a and B from the Cultured Cyanobacterium Calothrix Sp. Uic 10520.” Camila M. Crnkovic, Aleksej Krunic, Daniel S. May, Tyler A. Wilson, Diana Kao, Joanna E. Burdette, James R. Fuchs, Nicholas H. Oberlies, and Jimmy Orjala Journal of Natural Products, 2018, 81, 2083-2090. PMID: 30192537; PMCID: PMC6359934; doi: 10.1021/acs.jnatprod.8b00432 |
| 170 | “Fungal Planet Description Sheets: 716-784.” P.W. Crous, M.J. Wingfield, T.I. Burgess, G.E.St.J. Hardy, J. Gené, J. Guarro, I.G. Baseia, D. García, L.F.P. Gusmão, C.M. Souza-Motta, R. Thangavel, S. Adamčík, A. Barili, C.W. Barnes, J.D.P. Bezerra, J.J. Bordallo, J.F. Cano-Lira, R.J.V. de Oliveira, E. Ercole, V. Hubka, I. Iturrieta-González, A. Kubátová, M.P. Martín, P.-A. Moreau, A. Morte, M.E. Ordoñez, A. Rodríguez, A.M. Stchigel, A. Vizzini, J. Abdollahzadeh, V.P. Abreu, K. Adamčíková, G.M.R. Albuquerque, A.V. Alexandrova, E. Álvarez Duarte, C. Armstrong-Cho, S. Banniza, R.N. Barbosa, J.-M. Bellanger, J.L. Bezerra, T.S. Cabral, M. Caboň, E. Caicedo, T. Cantillo, A.J. Carnegie, L.T. Carmo, R.F. Castañeda-Ruiz, C.R. Clement, A. Čmoková, L.B. Conceição, R.H.S.F. Cruz, U. Damm, B.D.B. da Silva, G.A. da Silva, R.M.F. da Silva, A.L.C.M. de A. Santiago, L.F. de Oliveira, C.A.F. de Souza, F. Déniel, B. Dima, G. Dong, J. Edwards, C.R. Félix, J. Fournier, T.B. Gibertoni, K. Hosaka, T. Iturriaga, M. Jadan, J.-L. Jany, Ž. Jurjević, M. Kolařík, I. Kušan, M.F. Landell, T.R. Leite Cordeiro, D.X. Lima, M. Loizides, S. Luo, A.R. Machado, H. Madrid, O.M.C. Magalhães, P. Marinho, N. Matočec, A. Mešić, A.N. Miller, O.V. Morozova, R.P. Neves, K. Nonaka, A. Nováková, N.H. Oberlies, J.R.C. Oliveira-Filho, T.G.L. Oliveira, V. Papp, O.L. Pereira, G. Perrone, S.W. Peterson, T.H.G. Pham, H.A. Raja, D.B. Raudabaugh, J. Řehulka, E. Rodríguez-Andrade, M. Saba, A. Schauflerová, R.G. Shivas, G. Simonini, J.P.Z. Siqueira, J.O. Sousa, V. Stajsic, T. Svetasheva, Y.P. Tan, Z. Tkalčec, S. Ullah, P. Valente, N. Valenzuela-Lopez, M. Abrinbana, D.A. Viana Marques, P.T.W. Wong, V. Xavier de Lima, and J.Z. Groenewald Persoonia – Molecular Phylogeny and Evolution of Fungi, 2018, 40, 239-392. PMID: 30505003; PMCID: PMC6146637; doi: 10.3767/persoonia.2018.40.10 |
| 169 | “Reinforcement of Polymeric Nanoassemblies for Ultra-High Drug Loadings, Modulation of Stiffness and Release Kinetics, and Sustained Therapeutic Efficacy.” Iriny Ekladious, Rong Liu, Nitinun Varongchayakul, Luis A. Mejia Cruz, Daniel A. Todd, Heng Zhang, Nicholas H. Oberlies, Robert F. Padera, Yolonda L. Colson, and Mark W. Grinstaff Nanoscale, 2018, 10, 8360-8366. PMID: 29717728; doi: 10.1039/c8nr01978a |
| 168 | “Identification of Intestinal Udp-Glucuronosyltransferase Inhibitors in Green Tea (Camellia sinensis) Using a Biochemometric Approach: Application to Raloxifene as a Test Drug Via in Vitro to in Vivo Extrapolation.” Dan-Dan Tian, Joshua J. Kellogg, Neşe Okut, Nicholas H. Oberlies, Nadja B. Cech, Danny D. Shen, Jeannine S. McCune, and Mary F. Paine Drug Metabolism and Disposition, 2018, 46, 552. PMID: 29467215; PMCID: PMC5890833; doi: 10.1124/dmd.117.079491 |
| 167 | “Detection of Adulteration in Hydrastis canadensis (Goldenseal) Dietary Supplements via Untargeted Mass Spectrometry-Based Metabolomics.” Emily D. Wallace, Nicholas H. Oberlies, Nadja B. Cech, and Joshua J. Kellogg Food and Chemical Toxicology, 2018, 120, 439-447. PMID: 30031041; PMCID: PMC6434943; doi: 10.1016/j.fct.2018.07.033 |
| 166 | “Cytotoxic Homoisoflavonoids from the Bulbs of Bellevalia flexuosa.” Tamam El-Elimat, José Rivera-Chávez, Joanna E. Burdette, Austin Czarnecki, Maram B. Alhawarri, Mohammad Al-Gharaibeh, Feras Alali, and Nicholas H. Oberlies Fitoterapia, 2018, 127, 201-206. PMID: 29471027; PMCID: PMC5984119; doi: 10.1016/j.fitote.2018.02.022 |
| 165 | “Contrasting Roles of H3K4me3 and H3K9me3 in Regulation of Apoptosis and Gemcitabine Resistance in Human Pancreatic Cancer Cells.” Chunwan Lu, Dafeng Yang, Maria E. Sabbatini, Aaron H. Colby, Mark W. Grinstaff, Nicholas H. Oberlies, Cedric Pearce, and Kebin Liu BMC Cancer, 2018, 18, 149. PMID: 29409480; PMCID: PMC5801751; doi: 10.1186/s12885-018-4061-y |
| 164 | “Greensporone C, a Freshwater Fungal Secondary Metabolite Induces Mitochondrial-Mediated Apoptotic Cell Death in Leukemic Cell Lines.” Kirti S. Prabhu, Kodappully Sivaraman Siveen, Shilpa Kuttikrishnan, Ahmad N. Iskandarani, Abdul Q. Khan, Maysaloun Merhi, Halima E. Omri, Said Dermime, Tamam El-Elimat, Nicholas H. Oberlies, Feras Q. Alali, and Shahab Uddin Frontiers in Pharmacology, 2018, 9, 720. PMID: 30061828; PMCID: PMC6054921; doi: 10.3389/fphar.2018.00720 |
2017
| 163 | “Prealamethicin F50 and Related Peptaibols from Trichoderma arundinaceum: Validation of their Authenticity via in situ Chemical Analysis.” José Rivera-Chávez, Huzefa A. Raja, Tyler N. Graf, Jacklyn M. Gallagher, Prashant Metri, Ding Xue, Cedric J. Pearce, and Nicholas H. Oberlies RSC Advances, 2017, 7, 45733-45751. PMID: 29379602; PMCID: PMC5786278; doi: 10.1039/c7ra09602j |
| 162 | “Conventional and Accelerated-Solvent Extractions of Green Tea (Camellia sinensis) for Metabolomics-Based Chemometrics.” Joshua J. Kellogg, Emily D. Wallace, Tyler N. Graf, Nicholas H. Oberlies, and Nadja B. Cech Journal of Pharmaceutical and Biomedical Analysis, 2017, 145, 604-610. PMID: 28787673; PMCID: PMC5804813; doi: 10.1016/j.jpba.2017.07.027 |
| 161 | “Chemoselective Fluorination and Chemoinformatic Analysis of Griseofulvin: Natural vs Fluorinated Fungal Metabolites.” Noemi D. Paguigan, Mohammed H. Al-Huniti, Huzefa A. Raja, Austin Czarnecki, Joanna E. Burdette, Mariana González-Medina, José L. Medina-Franco, Stephen J. Polyak, Cedric J. Pearce, Mitchell P. Croatt, and Nicholas H. Oberlies Bioorganic & Medicinal Chemistry, 2017, 25, 5238-5246. PMID: 28802670; PMCID: PMC5632135; doi: 10.1016/j.bmc.2017.07.041 |
| 160 | “Biosynthesis of Fluorinated Peptaibols Using a Site-Directed Building Block Incorporation Approach.” José Rivera-Chávez, Huzefa A. Raja, Tyler N. Graf, Joanna E. Burdette, Cedric J. Pearce, and Nicholas H. Oberlies Journal of Natural Products, 2017, 80, 1883-1892. PMID: 28594169; PMCID: PMC5485375; doi: 10.1021/acs.jnatprod.7b00189 |
| 159 | “Synthesis of Poly(1,2-Glycerol Carbonate)-Paclitaxel Conjugates and Their Utility as a Single High-Dose Replacement for Multi-Dose Treatment Regimens in Peritoneal Cancer.” Iriny Ekladious, Rong Liu, Heng Zhang, Daniel H. Foil, Daniel A. Todd, Tyler N. Graf, Robert F. Padera, Nicholas H. Oberlies, Yolonda L. Colson, and Mark W. Grinstaff Chemical Science, 2017, 8, 8443-8450. PMID: 29619192; PMCID: PMC5863611; doi: 10.1039/C7SC03501B |
| 158 | “In Situ Mass Spectrometry Monitoring of Fungal Cultures Led to the Identification of Four Peptaibols with a Rare Threonine Residue.” Vincent P. Sica, Evan R. Rees, Huzefa A. Raja, José Rivera-Chávez, Joanna E. Burdette, Cedric J. Pearce, and Nicholas H. Oberlies Phytochemistry, 2017, 143, 45-53. PMID: 28772192; PMCID: PMC5603414; doi: 10.1016/j.phytochem.2017.07.004 |
| 157 | “Comparison of Metabolomics Approaches for Evaluating the Variability of Complex Botanical Preparations: Green Tea (Camellia sinensis) as a Case Study.” Joshua J. Kellogg, Tyler N. Graf, Mary F. Paine, Jeannine S. McCune, Olav M. Kvalheim, Nicholas H. Oberlies, and Nadja B. Cech Journal of Natural Products, 2017, 80, 1457-1466. PMID: 28453261; PMCID: PMC5469520; doi: 10.1021/acs.jnatprod.6b01156 |
| 156 | “Characterization and Isolation of Peptide Metabolites of an Antifungal Bacterial Isolate Identified as Bacillus Amyloliquefaciens Subspecies plantarum Strain FZB42.” Abiodun Adibi, Evan R. Rees, Saudia McCarley, Vincent P. Sica, and Nicholas H. Oberlies Journal of Microbiology, Biotechnology and Food Sciences, 2017, 6, 1309-1313. doi: 10.15414/jmbfs.2017.6.6.1309-1313 |
| 155 | “Secondary Metabolites from the Leaves of the Medicinal Plant Goldenseal (Hydrastis canadensis).” Martha Leyte-Lugo, Emily R. Britton, Daniel H. Foil, Adam R. Brown, Daniel A. Todd, José Rivera-Chávez, Nicholas H. Oberlies, and Nadja B. Cech Phytochemistry Letters, 2017, 20, 54-60. PMID: 28736584; PMCID: PMC5516942; doi: 10.1016/j.phytol.2017.03.012 |
| 154 | “qNMR for Profiling the Production of Fungal Secondary Metabolites.” Wilson C. Brooks, Noemi D. Paguigan, Huzefa A. Raja, Franklin J. Moy, Nadja B. Cech, Cedric J. Pearce, and Nicholas H. Oberlies Magnetic Resonance in Chemistry, 2017, 55, 670-676. PMID: 28024162; PMCID: PMC5459663; doi: 10.1002/mrc.4571 |
| 153 | “Additions to Lindgomyces (Lindgomycetaceae, Pleosporales, Dothideomycetes), Including Two New Species Occurring on Submerged Wood from North Carolina, USA, with Notes on Secondary Metabolite Profiles.” Huzefa A. Raja, Noemi D. Paguigan, Jacques Fournier, and Nicholas H. Oberlies Mycological Progress, 2017, 16, 535-552. doi: 10.1007/s11557-017-1282-4 |
| 152 | “Safety Assessment of Mushrooms in Dietary Supplements by Combining Analytical Data with in Silico Toxicology Evaluation.” Karen M. VanderMolen, Jason G. Little, Vincent P. Sica, Tamam El-Elimat, Huzefa A. Raja, Nicholas H. Oberlies, Timothy R. Baker, and Catherine Mahony Food and Chemical Toxicology, 2017, 103, 133-147. PMID: 28267567; doi: 10.1016/j.fct.2017.03.005 |
| 151 | “Plasma Pharmacokinetics and Bioavailability of Verticillin A Following Different Routes of Administration in Mice Using Liquid Chromatography Tandem Mass Spectrometry.” Jiang Wang, Xiaohua Zhu, Shamala Kolli, Hongyan Wang, Cedric J. Pearce, Nicholas H. Oberlies, and Mitch A. Phelps Journal of Pharmaceutical and Biomedical Analysis, 2017, 139, 187-192. PMID: 28284083; PMCID: PMC5399420; doi: 10.1016/j.jpba.2017.02.051 |
| 150 | “Fungal Identification Using Molecular Tools: A Primer for the Natural Products Research Community.” Huzefa A. Raja, Andrew N. Miller, Cedric J. Pearce, and Nicholas H. Oberlies Journal of Natural Products, 2017, 80, 756-770. PMID: 28199101; PMCID: PMC5368684; doi: 10.1021/acs.jnatprod.6b01085 |
| 149 | “DNA Barcoding for Identification of Consumer-Relevant Mushrooms: A Partial Solution for Product Certification?” Huzefa A. Raja, Timothy R. Baker, Jason G. Little, and Nicholas H. Oberlies Food Chemistry, 2017, 214, 383-392. PMID: 27507489; doi: 10.1016/j.foodchem.2016.07.052 |
| 148 | “Enhanced Dereplication of Fungal Cultures Via Use of Mass Defect Filtering.” Noemi D. Paguigan, Tamam El-Elimat, Diana Kao, Huzefa A. Raja, Cedric J. Pearce, and Nicholas H. Oberlies The Journal of Antibiotics, 2017, 70, 553-561. PMID: 28074050 PMCID; PMC5407915; doi: 10.1038/ja.2016.145 |
| 147 | “The MLL1-H3K4me3 Axis-Mediated PD-L1 Expression and Pancreatic Cancer Immune Evasion.” Chunwan Lu, Amy V. Paschall, Huidong Shi, Natasha Savage, Jennifer L. Waller, Maria E. Sabbatini, Nicholas H. Oberlies, Cedric Pearce, and Kebin Liu Journal of the National Cancer Institute, 2017, 109, djw283. PMID: 28131992 PMCID; PMC5291187; doi: 10.1093/jnci/djw283 |
| 146 | “Scaffold Diversity of Fungal Metabolites.” Mariana González-Medina, John R. Owen, Tamam El-Elimat, Cedric J. Pearce, Nicholas H. Oberlies, Mario Figueroa, and José L. Medina-Franco Frontiers in Pharmacology, 2017, 8, 180. PMID: 28420994; PMCID: PMC5376591; doi: 10.3389/fphar.2017.00180 |
| 145 | “Nanoparticle Drug-Delivery Systems for Peritoneal Cancers: A Case Study of the Design, Characterization and Development of the Expansile Nanoparticle.” Aaron H. Colby, Nicholas H. Oberlies, Cedric J. Pearce, Victoria L. M. Herrera, Yolonda L. Colson, and Mark W. Grinstaff Wiley Interdisciplinary Reviews: Nanomedicine and Nanobiotechnology, 2017, 9, e1451-n/a. PMID: 28185434; PMCID: PMC5389910; doi: 10.1002/wnan.1451 |
| 144 | “a-Pyrone Derivatives, Tetra/Hexahydroxanthones, and Cyclodepsipeptides from Two Freshwater Fungi.” Tamam El-Elimat, Huzefa A Raja, Cynthia S. Day, Hana McFeeters, Robert L. McFeeters, and Nicholas H. Oberlies Bioorganic & Medicinal Chemistry, 2017, 25, 795-804. PMID: 27964996; doi: 10.1016/j.bmc.2016.11.059 |
2016
| 143 | “Discovery of Anticancer Agents of Diverse Natural Origin.” Douglas Kinghorn, Esperanza J. Carcache De Blanco, David M. Lucas, H. Liva Rakotondraibe, Jimmy Orjala, D. Doel Soejarto, Nicholas H. Oberlies, Cedric J. Pearce, Mansukh C. Wani, Brent R. Stockwell, Joanna E. Burdette, Steven M. Swanson, James R. Fuchs, Mitchell A. Phelps, Lihui Xu, Xiaoli Zhang, and Young Yongchun Shen Anticancer Research, 2016, 36, 5623-5637. PMID: 27793884; PMCID: PMC5098703; doi: 10.21873/anticanres.11146 |
| 142 | “Chemoinformatic Expedition of the Chemical Space of Fungal Products.” Mariana González-Medina, Fernando D. Prieto-Martínez, J. Jesús Naveja, Oscar Méndez-Lucio, Tamam El-Elimat, Cedric J. Pearce, Nicholas H. Oberlies, Mario Figueroa, and José L. Medina-Franco Future Medicinal Chemistry, 2016, 8, 1399-1412. PMID: 27485744; PMCID: PMC5558535; doi: 10.4155/fmc-2016-0079 |
| 141 | “Antimicrobial Fungal Endophytes from the Botanical Medicine Goldenseal (Hydrastis canadensis).” Joseph M. Egan, Amninder Kaur, Huzefa A. Raja, Joshua J. Kellogg, Nicholas H.Oberlies, and Nadja B.Cech Phytochemistry Letters, 2016, 17, 219-225. PMID: 28603575; PMCID: PMC5461979; doi: 10.1016/j.phytol.2016.07.031 |
| 140 | “Secondary Metabolites from Fungal Endophytes of Echinacea purpurea Suppress Cytokine Secretion by Macrophage-Type Cells.” Amninder Kaur, Martina Oberhofer, Monika Juzumaite, Huzefa A. Raja, Travis V. Gulledge, Diana Kao, Stanley H. Faeth, Scott M. Laster, Nicholas H. Oberlies, and Nadja B. Cech Natural Product Communications, 2016, 11, 1143-1146. PMID: 28479944; PMCID: PMC5414731 |
| 139 | “In Situ Analysis of Asimina triloba (Paw Paw) Plant Tissues for Acetogenins via the Droplet-Liquid Microjunction-Surface Sampling Probe Coupled to UHPLC-PDA-HRMS/MS.” Vincent P .Sica, Tamam El-Elimat, and Nicholas H. Oberlies Analytical Methods, 2016, 8, 6143-6149. doi: 10.1039/C6AY01583B |
| 138 | “Verticillin A Inhibits Leiomyosarcoma and Malignant Peripheral Nerve Sheath Tumor Growth Via Induction of Apoptosis.” Abbie Zewdu, Gonzalo Lopez, Danielle Braggio, Connor Kenney, Constantino D, Hemant Bid, Kara Batte, O. Hans Iwenofu, Nicholas H. Oberlies, Cedric J. Pearce, Anne Strohecker, Dina Lev, and Raphael E. Pollock Clinical and Experimental Pharmacology, 2016, 06. PMID: 28184331; PMCID: PMC5295762; doi: 10.4172/2161-1459.1000221 |
| 137 | “Optimizing Production and Evaluating Biosynthesis in Situ of a Herbicidal Compound, Mevalocidin, from Coniolariella Sp.” Vincent P. Sica, Mario Figueroa, Huzefa A. Raja, Tamam El-Elimat, Blaise A. Darveaux, Cedric J. Pearce, and Nicholas H. Oberlies Journal of Industrial Microbiology & Biotechnology, 2016, 43, 1149-1157. PMID: 27221133; doi: 10.1007/s10295-016-1782-2 |
| 136 | “Silymarin Constituents Enhance ABCA1 Expression in THP-1 Macrophages.” Limei Wang, Susanne Rotter, Angela Ladurner, H. Elke Heiss, H. Nicholas Oberlies, M. Verena Dirsch, and G. Atanas Atanasov Molecules, 2016, 21, . PMID: 26729088; PMCID: PMC4748397; doi: 10.3390/molecules21010055 |
| 135 | “Spatial and Temporal Profiling of Griseofulvin Production in Xylaria cubensis Using Mass Spectrometry Mapping.” Vincent Sica, Evan Rees, Edem Tchegnon, Robert Bardsley, Huzefa Raja, and Nicholas Oberlies Frontiers in Microbiology, 2016, 7. PMID: 27199902; PMCID: PMC4844619; doi: 10.3389/fmicb.2016.00544 |
| 134 | “Acetophenone Derivatives from a Freshwater Fungal Isolate of Recently Described Lindgomyces Madisonensis (G416).” Noemi D. Paguigan, Huzefa A. Raja, Cynthia S. Day, and Nicholas H. Oberlies Phytochemistry, 2016, 126, 59-65. PMID: 26988728; doi: 10.1016/j.phytochem.2016.03.007 |
| 133 | “Biochemometrics for Natural Products Research: Comparison of Data Analysis Approaches and Application to Identification of Bioactive Compounds.” Joshua J. Kellogg, Daniel A. Todd, Joseph M. Egan, Huzefa A. Raja, Nicholas H. Oberlies, Olav M. Kvalheim, and Nadja B. Cech Journal of Natural Products, 2016, 79, 376-386. PMID: 26841051; PMCID: PMC5135737; doi: 10.1021/acs.jnatprod.5b01014 |
| 132 | “Talarolutins A–D: Meroterpenoids from an Endophytic Fungal Isolate of Talaromyces minioluteus.” Amninder Kaur, Huzefa A. Raja, Dale C. Swenson, Rajesh Agarwal, Gagan Deep, Joseph O. Falkinham III, and Nicholas H. Oberlies Phytochemistry, 2016, 126, 4-10. PMID: 27048854; PMCID: PMC4861051; doi: 10.1016/j.phytochem.2016.03.013 |
| 131 | “A Validated UHPLC-Tandem Mass Spectrometry Method for Quantitative Analysis of Flavonolignans in Milk Thistle (Silybum marianum) Extracts.” Tyler N. Graf, Nadja B. Cech, Stephen J. Polyak, and Nicholas H. Oberlies Journal of Pharmaceutical and Biomedical Analysis, 2016, 126, 26-33. PMID: 27136284; PMCID: PMC4893890; doi: 10.1016/j.jpba.2016.04.028 |
| 130 | “Graviola Inhibits Hypoxia-Induced NADPH Oxidase Activity in Prostate Cancer Cells Reducing Their Proliferation and Clonogenicity.” Gagan Deep, Rahul Kumar, Anil K. Jain, Deepanshi Dhar, Gati K. Panigrahi, Anowar Hussain, Chapla Agarwal, Tamam El-Elimat, Vincent P. Sica, Nicholas H. Oberlies, and Rajesh Agarwal Scientific Reports, 2016, 6, 23135. PMID: 26979487; PMCID: PMC4793251; doi: 10.1038/srep23135 |
| 129 | “Pannorin B, a New Naphthopyrone from an Endophytic Fungal Isolate of Penicillium Sp.” Amninder Kaur, Huzefa A. Raja, Gagan Deep, Rajesh Agarwal, and Nicholas H. Oberlies Magnetic Resonance in Chemistry, 2016, 54, 164-167. PMID: 26365944; doi: 10.1002/mrc.4324 |
2015
| 128 | “Fungal Planet Description Sheets: 371-399.” Crous, P. W., Wingfield, M. J., Le Roux, J. J., Richardson, D. M., Strasberg, D., Shivas, R. G., Alvarado, P., Edwards, J., Moreno, G., Sharma, R., Sonawane, M. S., Tan, Y. P., Altes, A., Barasubiye, T., Barnes, C. W., Blanchette, R. A., Boertmann, D., Bogo, A., Carlavilla, J. R., Cheewangkoon, R., Daniel, R., de Beer, Z. W., de Jesus Yanez-Morales, M., Duong, T. A., Fernandez-Vicente, J., Geering, A. D., Guest, D. I., Held, B. W., Heykoop, M., Hubka, V., Ismail, A. M., Kajale, S. C., Khemmuk, W., Kolarik, M., Kurli, R., Lebeuf, R., Levesque, C. A., Lombard, L., Magista, D., Manjon, J. L., Marincowitz, S., Mohedano, J. M., Novakova, A., Oberlies, N. H., Otto, E. C., Paguigan, N. D., Pascoe, I. G., Perez-Butron, J. L., Perrone, G., Rahi, P., Raja, H. A., Rintoul, T., Sanhueza, R. M., Scarlett, K., Shouche, Y. S., Shuttleworth, L. A., Taylor, P. W., Thorn, R. G., Vawdrey, L. L., Solano-Vidal, R., Voitk, A., Wong, P. T., Wood, A. R., Zamora, J. C., and Groenewald, J. Z. Persoonia, 2015, 35, 264-327. PMID: 26823636; PMCID: PMC4713108; doi: 10.3767/003158515X690269 |
| 127 | “H3K9 Trimethylation Silences FASs Expression to Confer Colon Carcinoma Immune Escape and 5-Fluorouracil Chemoresistance.” Amy V. Paschall, Dafeng Yang, Chunwan Lu, Jeong-Hyeon Choi, Xia Li, Feiyan Liu, Mario Figueroa, Nicholas H. Oberlies, Cedric Pearce, Wendy B. Bollag, Asha Nayak-Kapoor, and Kebin Liu The Journal of Immunology, 2015, 195, 1868-1882. PMID: 26136424; PMCID: PMC4530033; doi: 10.4049/jimmunol.1402243 |
| 126 | “Minutisphaerales (Dothideomycetes, Ascomycota): A New Order of Freshwater Ascomycetes Including a New Family, Minutisphaeraceae, and Two New Species from North Carolina, USA.” Huzefa A. Raja, Tamam El-Elimat, Nicholas H. Oberlies, Carol A. Shearer, Andrew N. Miller, Kazuaki Tanaka, Akira Hashimoto, and Jacques Fournier Mycologia, 2015, 107, 845-862. PMID: 26315030; doi: 10.3852/15-013 |
| 125 | “Silymarin Suppresses Cellular Inflammation by Inducing Reparative Stress Signaling.” Erica S. Lovelace, Jessica Wagoner, James MacDonald, Theo Bammler, Jacob Bruckner, Jessica Brownell, Richard P. Beyer, Erika M. Zink, Young-Mo Kim, Jennifer E. Kyle, Bobbie-Jo M. Webb-Robertson, Katrina M. Waters, Thomas O. Metz, Federico Farin, Nicholas H. Oberlies, and Stephen J. Polyak Journal of Natural Products, 2015, 78, 1990-2000. PMID: 26186142; PMCID: PMC4703094; doi: 10.1021/acs.jnatprod.5b00288 |
| 124 | “Isolation, Semisynthesis, Covalent Docking and Transforming Growth Factor Beta-Activated Kinase 1 (TAK1)-Inhibitory Activities of (5Z)-7-Oxozeaenol Analogues.” Lara Fakhouri, Tamam El-Elimat, Dow P. Hurst, Patricia H. Reggio, Cedric J. Pearce, Nicholas H. Oberlies, and Mitchell P. Croatt Bioorganic & Medicinal Chemistry, 2015, 23, 6993-6999. PMID: 26481152; PMCID: PMC4661079; doi: 10.1016/j.bmc.2015.09.037 |
| 123 | “Milk Thistle Constituents Inhibit Raloxifene Intestinal Glucuronidation: A Potential Clinically Relevant Natural Product–Drug Interaction.” Brandon T. Gufford, Gang Chen, Ana G. Vergara, Philip Lazarus, Nicholas H. Oberlies, and Mary F. Paine Drug Metabolism and Disposition, 2015, 43, 1353-1359. PMID: 26070840; PMCID: PMC4538855; doi: 10.1124/dmd.115.065086 |
| 122 | “Chemoenzymatic Synthesis, Characterization, and Scale-up of Milk Thistle Flavonolignan Glucuronides.” Brandon T. Gufford, Tyler N. Graf, Noemi D. Paguigan, Nicholas H. Oberlies, and Mary F. Paine Drug Metabolism and Disposition, 2015, 43, 1734-1743. PMID: 26316643; PMCID: PMC4613946; doi: 10.1124/dmd.115.066076 |
| 121 | “Spiroscytalin, a New Tetramic Acid and Other Metabolites of Mixed Biogenesis fromScytalidium cuboideum.” Arlene A. Sy-Cordero, Mario Figueroa, Huzefa A. Raja, Maria Elena Meza Aviña, Mitchell P. Croatt, Audrey F. Adcock, David J. Kroll, Mansukh C. Wani, Cedric J. Pearce, and Nicholas H. Oberlies Tetrahedron, 2015, 71, 8899-8904. PMID: 26525642; PMCID: PMC4624200; doi: 10.1016/j.tet.2015.09.073 |
| 120 | “Cytotoxic Homoisoflavones from the Bulbs of Bellevalia eigii.” Feras Q. Alali, Tamam El-Elimat, Hanan Albataineh, Qosay Al-Balas, Mohammad Al-Gharaibeh, Joseph O. Falkinham, Wei-Lun Chen, Steven M. Swanson, and Nicholas H. Oberlies Journal of Natural Products, 2015, 78, 1708-1715. PMID: 26147490; PMCID: PMC4615712; doi: 10.1021/acs.jnatprod.5b00357 |
| 119 | “New Diketopiperazine Dimer from a Filamentous Fungal Isolate of Aspergillus sydowii.” Amninder Kaur, Huzefa A. Raja, Blaise A. Darveaux, Wei-Lun Chen, Steven M. Swanson, Cedric J. Pearce, and Nicholas H. Oberlies Magnetic Resonance in Chemistry, 2015, 53, 616-619. PMID: 26040447; PMCID: PMC4692248; doi: 10.1002/mrc.4254 |
| 118 | “Dereplicating and Spatial Mapping of Secondary Metabolites from Fungal Cultures in Situ.” Vincent P .Sica, Huzefa A. Raja, Tamam El-Elimat, Vilmos Kertesz, Gary J.Van Berkel, Cedric J.Pearce, and Nicholas H.Oberlies Journal of Natural Products, 2015, 78, 1926-1936. PMID: 26192135; PMCID: PMC4570219; doi: 10.1021/acs.jnatprod.5b00268 |
| 117 | “Ethanolic Echinacea purpurea Extracts Contain a Mixture of Cytokine-Suppressive and Cytokine-Inducing Compounds, Including Some That Originate from Endophytic Bacteria.” Daniel A. Todd, Travis V. Gulledge, Emily R. Britton, Martina Oberhofer, Martha Leyte-Lugo, Ashley N. Moody, Tatsiana Shymanovich, Laura F. Grubbs, Monika Juzumaite, Tyler N. Graf, Nicholas H. Oberlies, Stanley H. Faeth, Scott M. Laster, and Nadja B. Cech Plos One, 2015, 10, e0124276. PMID: 25933416; PMCID: PMC4416932; doi: 10.1371/journal.pone.0124276 |
| 116 | “Phylogenetic and Chemical Diversity of Fungal Endophytes Isolated from Silybum marianum(L) Gaertn. (Milk Thistle).” Huzefa A. Raja, Amninder Kaur, Tamam El-Elimat, Mario Figueroa, Rahul Kumar, Gagan Deep, Rajesh Agarwal, Stanley H. Faeth, Nadja B. Cech, and Nicholas H. Oberlies Mycology, 2015, 6, 8-27. PMID: 26000195; PMCID: PMC4409047; doi:10.1080/21501203.2015.1009186 |
| 115 | “Ω-Hydroxyemodin Limits Staphylococcus aureus Quorum Sensing-Mediated Pathogenesis and Inflammation.” Seth M. Daly, Bradley O. Elmore, Jeffrey S. Kavanaugh, Kathleen D. Triplett, Mario Figueroa, Huzefa A. Raja, Tamam El-Elimat, Heidi A. Crosby, Jon K. Femling, Nadja B. Cech, Alexander R. Horswill, Nicholas H. Oberlies, and Pamela R. Hall Antimicrobial Agents and Chemotherapy, 2015, 59, 2223-2235. PMID: 25645827; PMCID: PMC4356798; doi: 10.1128/AAC.04564-14 |
| 114 | “Comparison of the Chemistry and Diversity of Endophytes Isolated from Wild-Harvested and Greenhouse-Cultivated Yerba mansa (Anemopsis californica).” Robert O. Bussey III, Amninder Kaur, Daniel A. Todd, Joseph M. Egan, Tamam El-Elimat, Tyler N. Graf, Huzefa A. Raja, Nicholas H. Oberlies, and Nadja B. Cech Phytochemistry Letters, 2015, 11, 202-208. PMID: 25642298; PMCID: PMC4307022; doi:10.1016/j.phytol.2014.12.013 |
| 113 | “Sorbicillinoid Analogs with Cytotoxic and Selective Anti-Aspergillus Activities fromScytalidium album.” Tamam El-Elimat, Huzefa A. Raja, Mario Figueroa, Steven M. Swanson, Joseph O. Falkinham III, David M. Lucas, Michael R. Grever, Mansukh C. Wani, Cedric J. Pearce, and Nicholas H. Oberlies The Journal of Antibiotics, 2015, 68, 191-196. PMID: 25248727; PMCID: PMC4372511; doi: 10.1038/ja.2014.125 |
| 112 | “Biosynthetically Distinct Cytotoxic Polyketides from Setophoma terrestris.” Tamam El-Elimat, Mario Figueroa, Huzefa A. Raja, Tyler N. Graf, Steven M. Swanson, Joseph O. Falkinham, Mansukh C. Wani, Cedric J. Pearce, and Nicholas H. Oberlies European Journal of Organic Chemistry, 2015, 2015, 109-121. PMID: 25574154; PMCID: PMC4283843; doi: 10.1002/ejoc.201402984 |
| 111 | “Inhibition of Human Aldehyde Oxidase Activity by Diet-Derived Constituents: Structural Influence, Enzyme-Ligand Interactions, and Clinical Relevance.” John T. Barr, Jeffrey P. Jones, Nicholas H. Oberlies, and Mary F. Paine Drug Metabolism and Disposition, 2015, 43, 34-41. PMID: 25326286; PMCID: PMC4279085; doi: 10.1124/dmd.114.061192 |
2014
| 110 | “Mass Spectrometry Imaging of Secondary Metabolites Directly on Fungal Cultures.” Vincent P. Sica, Huzefa A. Raja, Tamam El-Elimat, and Nicholas H. Oberlies RSC Advances, 2014, 4, 63221-63227. doi: 10.1039/C4RA11564C |
| 109 | “Identification of Diet-Derived Constituents as Potent Inhibitors of Intestinal Glucuronidation.” Brandon T. Gufford, Gang Chen, Philip Lazarus, Tyler N. Graf, Nicholas H. Oberlies, and Mary F. Paine Drug Metabolism and Disposition, 2014, 42, 1675-1683. PMID: 25008344; PMCID: PMC4164973; doi: 10.1124/dmd.114.059451 |
| 108 | “Greensporones: Resorcylic Acid Lactones from an Aquatic Halenospora Sp.” Tamam El-Elimat, Huzefa A. Raja, Cynthia S. Day, Wei-Lun Chen, Steven M. Swanson, and Nicholas H. Oberlies Journal of Natural Products, 2014, 77, 2088-2098. PMID: 25093280; PMCID: PMC4176394; doi: 10.1021/np500497r |
| 107 | “Bioactive Withanolides from Withania obtusifolia.” Feras Q. Alali, Chiraz Soumia M. Amrine, Tamam El-Elimat, Ahmad Alkofahi, Khaled Tawaha, Mohammad Gharaibah, Steven M. Swanson, Joseph O. Falkinham III, Marisa Cabeza, Araceli Sánchez, Mario Figueroa, and Nicholas H. Oberlies Phytochemistry Letters, 2014, 9, 96-101. doi:10.1016/j.phytol.2014.05.002 |
| 106 | “Antimycobacterial Furofuran Lignans from the Roots of Anemopsis californica.” Robert O. Bussey III, Arlene A. Sy-Cordero, Mario Figueroa, Fredrick S. Carter, Joseph O. Falkinham III, Nicholas H. Oberlies, and Nadja B. Cech Planta Medica, 2014, 80, 498-501. PMID: 24687738; PMCID: PMC4586282; doi: 10.1055/s-0034-1368352 |
| 105 | “Labeled Content of Two Furanocoumarins in Dietary Supplements Correlates with Neither Actual Content nor CYP3A Inhibitory Activity.” Karen M. VanderMolen, Garrett R. Ainslie, Mary F. Paine, and Nicholas H. Oberlies Journal of Pharmaceutical and Biomedical Analysis, 2014, 98, 260-265. PMID: 24951959; PMCID: PMC4180667; doi: 10.1016/j.jpba.2014.05.038 |
| 104 | “Identification of Isosilybin A from Milk Thistle Seeds as an Agonist of Peroxisome Proliferator-Activated Receptor Gamma.” Eva-Maria Pferschy-Wenzig, Atanas G. Atanasov, Clemens Malainer, Stefan M. Noha, Olaf Kunert, Daniela Schuster, Elke H. Heiss, Nicholas H. Oberlies, Hildebert Wagner, Rudolf Bauer, and Verena M. Dirsch Journal of Natural Products, 2014, 77, 842-847. PMID: 24597776; PMCID: PMC4003856; doi: 10.1021/np400943b |
| 103 | “Epigenetic Manipulation of a Filamentous Fungus by the Proteasome-Inhibitor Bortezomib Induces the Production of an Additional Secondary Metabolite.” Karen M. VanderMolen, Blaise A. Darveaux, Wei-Lun Chen, Steven M. Swanson, Cedric J. Pearce, and Nicholas H. Oberlies RSC advances, 2014, 4, 18329-18335. PMID: 24955237; PMCID: PMC4061710; doi: 10.1039/c4ra00274a |
| 102 | “Polyhydroxyanthraquinones as Quorum Sensing Inhibitors from the Guttates of Penicilliumrestrictum and Their Analysis by Desorption Electrospray Ionization Mass Spectrometry.” Mario Figueroa, Alan K. Jarmusch, Huzefa A. Raja, Tamam El-Elimat, Jeffrey S. Kavanaugh, Alexander R. Horswill, R. Graham Cooks, Nadja B. Cech, and Nicholas H. Oberlies Journal of Natural Products, 2014, 77, 1351-1358. PMID: 24911880; PMCID: PMC4073659; doi: 10.1021/np5000704 |
| 101 | “Isochromenones, Isobenzofuranone, and Tetrahydronaphthalenes Produced by Paraphoma radicina, a Fungus Isolated from a Freshwater Habitat.” Tamam El-Elimat, Huzefa A. Raja, Mario Figueroa, Joseph O. Falkinham III, and Nicholas H. Oberlies Phytochemistry, 2014, 104, 114-120. PMID: 24833033; doi: 10.1016/j.phytochem.2014.04.006 |
| 100 | “Flavonolignans from Aspergillus iizukae, a Fungal Endophyte of Milk Thistle (Silybum marianum).” Tamam El-Elimat, Huzefa A. Raja, Tyler N. Graf, Stanley H. Faeth, Nadja B. Cech, and Nicholas H. Oberlies Journal of Natural Products, 2014, 77, 193-199. PMID: 24456525; doi: 10.1021/np400955q |
| 99 | “Physiologically Based Pharmacokinetic Modeling Framework for Quantitative Prediction of an Herb-Drug Interaction.” Scott J. Brantley, Brandon T. Gufford, R Dua, Daryl J. Fediuk, Tyler N. Graf, Yolanda V. Scarlett, Kosea S. Frederick, Matthew B. Fisher, Nicholas H. Oberlies, and Mary F. Paine CPT: Pharmacometrics & Systems Pharmacology, 2014, 3, e107. PMID: 24670388; PMCID: PMC4042458; doi: 10.1038/psp.2013.69 |
2013
| 98 | “Evaluation of Culture Media for the Production of Secondary Metabolites in a Natural Products Screening Program.” Karen M. VanderMolen, Huzefa A. Raja, Tamam El-Elimat, and Nicholas H. Oberlies AMB Express, 2013, 3, 71. PMID: 24342059; PMCID: PMC3917616; doi: 10.1186/2191-0855-3-71 |
| 97 | “High-Resolution MS, MS/MS, and UV Database of Fungal Secondary Metabolites as a Dereplication Protocol for Bioactive Natural Products.” Tamam El-Elimat, Mario Figueroa, Brandie M. Ehrmann, Nadja B. Cech, Cedric J. Pearce, and Nicholas H. Oberlies Journal of Natural Products, 2013, 76, 1709-1716. PMID: 23947912; PMCID: PMC3856222; doi: 10.1021/np4004307 |
| 96 | “Silibinin Inhibits Hepatitis C Virus Entry into Hepatocytes by Hindering Clathrin-Dependent Trafficking.” Julie Blaising, Pierre L. Lévy, Claire Gondeau, Capucine Phelip, Mihayl Varbanov, Elodie Teissier, Florence Ruggiero, Stephen J. Polyak, Nicholas H. Oberlies, Tijana Ivanovic, Steeve Boulant, and Eve-Isabelle Pécheur Cellular Microbiology, 2013, 15, 1866-1882. PMID: 23701235; doi: 10.1111/cmi.12155 |
| 95 | “Rapid Quantitation of Furanocoumarins and Flavonoids in Grapefruit Juice Using Ultra-Performance Liquid Chromatography.” Karen M. VanderMolen, Nadja B. Cech, Mary F. Paine, and Nicholas H. Oberlies Phytochemical Analysis, 2013, 24, 654-660. PMID: 23780830; PMCID: PMC3855432; doi: 10.1002/pca.2449 |
| 94 | “A Modified Grapefruit Juice Eliminates Two Compound Classes as Major Mediators of the Grapefruit Juice–Fexofenadine Interaction: An in Vitro–in Vivo “Connect”.” Christina S. Won, Tian Lan, Karen M. VanderMolen, Paul A. Dawson, Nicholas H. Oberlies, Wilbur W. Widmer, Yolanda V. Scarlett, and Mary F. Paine The Journal of Clinical Pharmacology, 2013, 53, 982-990. PMID: 23878024; PMCID: PMC4029847; doi: 10.1002/jcph.136 |
| 93 | “Waol A, Trans-Dihydrowaol A, and Cis-Dihydrowaol A: Polyketide-Derived Γ-Lactones from aVolutella Species.” Tamam El-Elimat, Mario Figueroa, Huzefa A. Raja, Audrey F. Adcock, David J. Kroll, Steven M. Swanson, Mansukh C. Wani, Cedric J. Pearce, and Nicholas H. Oberlies Tetrahedron Letters, 2013, 54, 4300-4302. PMID: 23956472; PMCID: PMC3743556; doi: 10.1016/j.tetlet.2013.06.008 |
| 92 | “Peptaibols, Tetramic Acid Derivatives, Isocoumarins, and Sesquiterpenes from a Bionectria Sp. (MSX 47401).” Mario Figueroa, Huzefa Raja, Joseph O. Falkinham, Audrey F. Adcock, David J. Kroll, Mansukh C. Wani, Cedric J. Pearce, and Nicholas H. Oberlies Journal of Natural Products, 2013, 76, 1007-1015. PMID: 23806109; PMCID: PMC3736820; doi: 10.1021/np3008842 |
| 91 | “Mechanistic Study of the Biomimetic Synthesis of Flavonolignan Diastereoisomers in Milk Thistle.” Hanan S. Althagafy, Maria Elena Meza-Aviña, Nicholas H. Oberlies, and Mitchell P. Croatt The Journal of Organic Chemistry, 2013, 78, 7594-7600. PMID: 23876147; PMCID: PMC3855429; doi: 10.1021/Jo401137 |
| 90 | “A Systematic Approach to Evaluate Herb-Drug Interaction Mechanisms: Investigation of Milk Thistle Extracts and Eight Isolated Constituents as CYP3A Inhibitors.” Scott J. Brantley, Tyler N. Graf, Nicholas H. Oberlies, and Mary F. Paine Drug Metabolism and Disposition, 2013, 41, 1662-1670. PMID: 23801821; PMCID: PMC3876807; doi: 10.1124/dmd.113.052563 |
| 89 | “Semisynthesis, Cytotoxicity, Antiviral Activity, and Drug Interaction Liability of 7-O-Methylated Analogues of Flavonolignans from Milk Thistle.” Hanan S. Althagafy, Tyler N. Graf, Arlene A. Sy-Cordero, Brandon T. Gufford, Mary F. Paine, Jessica Wagoner, Stephen J. Polyak, Mitchell P. Croatt, and Nicholas H. Oberlies Bioorganic & Medicinal Chemistry, 2013, 21, 3919-3926. PMID: 23673225; PMCID: PMC3855444; doi: 10.1016/j.bmc.2013.04.017 |
| 88 | “HiFSA Fingerprinting Applied to Isomers with near-Identical NMR Spectra: The Silybin/Isosilybin Case.” José G. Napolitano, David C. Lankin, Tyler N. Graf, J. Brent Friesen, Shao-Nong Chen, James B. McAlpine, Nicholas H. Oberlies, and Guido F. Pauli Journal of Organic Chemistry, 2013, 78, 2827-2839. PMID: 23461697; PMCID: PMC3640553; doi: 10.1021/jo302720h |
| 87 | “Benzoquinones and Terphenyl Compounds as Phosphodiesterase-4B Inhibitors from a Fungus of the Order Chaetothyriales (MSX 47445).” Tamam El-Elimat, Mario Figueroa, Huzefa A. Raja, Tyler N. Graf, Audrey F. Adcock, David J. Kroll, Cynthia S. Day, Mansukh C. Wani, Cedric J. Pearce, and Nicholas H. Oberlies Journal of Natural Products, 2013, 76, 382-387. PMID: 23301853; PMCID: PMC3606633; doi: 10.1021/np300749w |
| 86 | “Silymarin for HCV Infection.” Stephen J. Polyak, Nicholas H. Oberlies, Eve-Isabelle Pécheur, Harel Dahari, Peter Ferenci, and Jean-Michel Pawlotsky Antiviral Therapy, 2013, 18, 141-147. PMID: 23011959; PMCID: PMC4076489; doi: 10.3851/imp2402 |
| 85 | “Interaction of Silymarin Flavonolignans with Organic Anion-Transporting Polypeptides.” Kathleen Köck, Ying Xie, Roy L. Hawke, Nicholas H. Oberlies, and Kim L. R. Brouwer Drug Metabolism and Disposition, 2013, 41, 958-965. PMID: 23401473; PMCID: PMC3629808; doi: 10.1124/dmd.112.048272 |
| 84 | “Sarothrin from Alkanna Orientalis Is an Antimicrobial Agent and Efflux Pump Inhibitor.” Jessica R. Bame, Tyler N. Graf, Hiyas A. Junio, R. Owen Bussey, Scott A. Jarmusch, Tamam El-Elimat, Joseph O. Falkinham, Nicholas H. Oberlies, Richard A. Cech, and Nadja B. Cech Planta Medica, 2013, 79, 327-329. PMID: 23468310; PMCID: PMC4527991; doi: 10.1055/s-0032-1328259 |
| 83 | “Enhanced Bioactivity of Silybin B Methylation Products.” Arlene A. Sy-Cordero, Tyler N. Graf, Scott P. Runyon, Mansukh C. Wani, David J. Kroll, Rajesh Agarwal, Scott J. Brantley, Mary F. Paine, Stephen J. Polyak, and Nicholas H. Oberlies Bioorganic & Medicinal Chemistry, 2013, 21, 742-747. PMID: 23260576; PMCID: PMC3630461; doi: 10.1016/j.bmc.2012.11.035 |
| 82 | “Freshwater Ascomycetes: Minutisphaera (Dothideomycetes) revisited, including one new species from Japan.” Huzefa Raja, Kazuaki Tanaka, Kazuyuki Hirayama, Akira Hoshimoto, Nicholas H. Oberlies, Mario Figueroa, Andrew N. Miller, Steven E. Zelski, and Carol A. Shearer. Mycologia, 2013, 105, 959-976. PMID: 23709484; doi: 10.3852/12-313 |
| 81 | “Lindgomyces angustiascus, (Lindgomycetaceae, Pleosporales, Dothideomycetes), a new lignicolous species from freshwater habitats in the USA” Huzefa Raja, Nicholas H. Oberlies, Tamama El Elimat, Andrew N. Miller, Steve Zelski, and Carol A. Shearer. Mycoscience, 2013, 54, 353-361. doi: 10.1016/j.myc.2012.12.004 |
2012
| 80 | “Absolute Configuration of Isosilybin a by X-Ray Crystallography of the Heavy Atom Analogue 7-(4-Bromobenzoyl)Isosilybin A.” Arlene A. Sy-Cordero, Cynthia S. Day, and Nicholas H. Oberlies Journal of Natural Products, 2012, 75, 1879-1881. PMID: 23116206; PMCID: PMC3620721; doi: 10.1021/np3005369 |
| 79 | “Cytotoxic Epipolythiodioxopiperazine Alkaloids from Filamentous Fungi of the Bionectriaceae.” Mario Figueroa, Tyler N. Graf, Sloan Ayers, Audrey F. Adcock, David J. Kroll, Jilai Yang, Steven M. Swanson, Ulyana Munoz-Acuna, Esperanza J. Carcache de Blanco, Rajesh Agrawal, Mansukh C. Wani, Blaise A. Darveaux, Cedric J. Pearce, and Nicholas H. Oberlies. Journal of Antibiotics, 2012, 65, 559-564. PMID: 22968289; PMCID: PMC3573876; doi: 10.1038/ja.2012.69 |
| 78 | “Revisiting the Enniatins: A Review of Their Isolation, Biosynthesis, Structure Determination and Biological Activities.” Arlene A. Sy-Cordero, Cedric J. Pearce, and Nicholas H. Oberlies. Journal of Antibiotics, 2012, 65, 541-549. PMID: 22990381; PMCID: PMC3573854; doi: 10.1038/ja.2012.71 |
| 77 | “Use of the Hollow Fiber Assay for the Discovery of Novel Anticancer Agents from Fungi.” Cedric J. Pearce, Daniel D. Lantvit, Qi Shen, David Jarjoura, Xiaoli Zhang, Nicholas H. Oberlies, David J. Kroll, Mansukh C. Wani, Jimmy Orjala, Djaja D. Soejarto, Norman R. Farnsworth, Esperanza J. Carcache Blanco, James R. Fuchs, A. Douglas Kinghorn, and Steven M. Swanson. Methods in Molecular Biology 2012, 944, 267-277. PMID: 23065624; doi: 10.1007/978-1-62703-122-6_20 |
| 76 | “Mechanisms Underlying Food–Drug Interactions: Inhibition of Intestinal Metabolism and Transport.” Christina S. Won, Nicholas H. Oberlies, and Mary F. Paine Pharmacology & Therapeutics, 2012, 136, 186-201. PMID: 22884524; PMCID: PMC3466398; doi: 10.1016/j.pharmthera.2012.08.001 |
| 75 | “Angiopreventive Efficacy of Pure Flavonolignans from Milk Thistle Extract against Prostate Cancer: Targeting VEGF-VEGFR Signaling.” Gagan Deep, Subhash C. Gangar, Subapriya Rajamanickam, Komal Raina, Mallikarjuna Gu, Chapla Agarwal, Nicholas H. Oberlies, and Rajesh Agarwal PLoS One, 2012, 7, e34630. PMID: 22514647; PMCID: PMC3326063; doi: 10.1371/journal.pone.0034630 |
| 74 | “Peptaibols from Two Unidentified Fungi of the Order Hypocreales with Cytotoxic, Antibiotic, and Anthelmintic Activities.” Sloan Ayers, Brandie M. Ehrmann, Audrey F. Adcock, David J. Kroll, Esperanza J. Carcache de Blanco, Qi Shen, Steven M. Swanson, Joseph O. Falkinham, Mansukh C. Wani, Sheila M. Mitchell, Cedric J. Pearce, and Nicholas H. Oberlies Journal of Peptide Science, 2012, 18, 500-510. PMID: 22744757; PMCID: PMC3494480; doi: 10.1002/psc.2425 |
| 73 | “Chemical Diversity of Metabolites from Fungi, Cyanobacteria, and Plants Relative to FDA-Approved Anticancer Agents.” Tamam El-Elimat, Xiaoli Zhang, David Jarjoura, Franklin J. Moy, Jimmy Orjala, A. Douglas Kinghorn, Cedric J. Pearce, and Nicholas H. Oberlies ACS Medicinal Chemistry Letters, 2012, 3, 645-649. PMID: 22993669; PMCID: PMC3443637; doi: 10.1021/ml300105s |
| 72 | “Effects of (5z)-7-Oxozeaenol on MDA-MB-231 Breast Cancer Cells.” Ulyana Muñoz Acuña, Jennifer Wittwer, Sloan Ayers, Cedric J. Pearce, Nicholas H. Oberlies, and Esperanza J. Carcache de Blanco Anticancer Research, 2012, 32, 2415-2421. PMID: 22753698; PMCID: PMC3563245; https://ar.iiarjournals.org/content/32/7/2415.abstract |
| 71 | “Effects of (5z)-7-Oxozeaenol on the Oxidative Pathway of Cancer Cells.” Ulyana Muñoz Acuña, Jennifer Wittwer, Sloan Ayers, Cedric J. Pearce, Nicholas H. Oberlies, and Esperanza J. Carcache de Blanco Anticancer Research, 2012, 32, 2665-2671. PMID: 22753724; PMCID: PMC3563252; https://ar.iiarjournals.org/content/32/7/2665.abstract |
| 70 | “Cytotoxic Xanthone-Anthraquinone Heterodimers from an Unidentified Fungus of the Order Hypocreales (MSX 17022).” Sloan Ayers, Tyler N. Graf, Audrey F. Adcock, David J. Kroll, Qi Shen, Steven M. Swanson, Susan Matthew, Esperanza J. Carcache de Blanco, Mansukh C. Wani, Blaise A. Darveaux, Cedric J. Pearce, and Nicholas H. Oberlies Journal of Antibiotics, 2012, 65, 3-8. PMID: 22068158; PMCID: PMC3267898; doi: 10.1038/ja.2011.95 |
2011
| 69 | “Thielavin B Methyl Ester: A Cytotoxic Benzoate Trimer from an Unidentified Fungus (MSX 55526) from the Order Sordariales.” Sloan Ayers, Brandie M. Ehrmann, Audrey F. Adcock, David J. Kroll, Mansukh C. Wani, Cedric J. Pearce, and Nicholas H. Oberlies Tetrahedron Letters, 2011, 52, 5733-5735. doi: 10.1016/j.tetlet.2011.08.125 |
| 68 | “Differential in Vitro Effects of Intravenous Versus Oral Formulations of Silibinin on the HCV Life Cycle and Inflammation.” Jessica Wagoner, Chihiro Morishima, Tyler N. Graf, Nicholas H. Oberlies, Elodie Teissier, Eve-Isabelle Pécheur, John E. Tavis, and Stephen J. Polyak PLoS One, 2011, 6, e16464. PMID:21297992; PMC3030583; doi: 10.1371/journal.pone.0016464 |
| 67 | “Resorcylic Acid Lactones with Cytotoxic and NF-kB Inhibitory Activities and Their Structure-Activity Relationships.” Sloan Ayers, Tyler N. Graf, Audrey F. Adcock, David J. Kroll, Susan Matthew, Esperanza J. Carcache de Blanco, Qi Shen, Steven M. Swanson, Mansukh C. Wani, Cedric J. Pearce, and Nicholas H. Oberlies Journal of Natural Products, 2011, 74, 1126-1131. PMID:21513293; PMCID: PMC3111092; doi: 10.1021/np200062x |
| 66 | “Isolation and Identification of Intestinal CYP3A Inhibitors from Cranberry (Vaccinium macrocarpon) Using Human Intestinal Microsomes.” Eunkyung Kim, Arlene Sy-Cordero, Tyler N. Graf, Scott J. Brantley, Mary F. Paine, and Nicholas H. Oberlies Planta Medica, 2011, 77, 265-270. PMID:20717876; PMCID: PMC3023844; doi: 10.1055/s-0030-1250259 |
| 65 | “Synergy-Directed Fractionation of Botanical Medicines: A Case Study with Goldenseal (Hydrastis canadensis).” Hiyas A. Junio, Arlene A. Sy-Cordero, Keivan A. Ettefagh, Johnna T. Burns, Kathryn T. Micko, Tyler N. Graf, Scott J. Richter, Robert E. Cannon, Nicholas H. Oberlies, and and Nadja B. Cech Journal of Natural Products, 2011, 74, 1621-1629. PMID:21661731; PMCID: PMC3142294; doi: 10.1021/np200336g |
| 64 | “Obionin B: An O-Pyranonaphthoquinone Decaketide from an Unidentified Fungus (MSX 63619) from the Order Pleosporales.” Sloan Ayers, Tyler N. Graf, Audrey F. Adcock, David J. Kroll, Qi Shen, Steven M. Swanson, Mansukh C. Wani, Blaise A. Darveaux, Cedric J. Pearce, and Nicholas H. Oberlies Tetrahedron Letters, 2011, 52, 5128-5230. PMID:22025810; PMCID: PMC3183506; doi: 10.1016/j.tetlet.2011.07.102 |
| 63 | “Cyclodepsipeptides, Sesquiterpenoids, and Other Cytotoxic Metabolites from the Filamentous Fungus Trichothecium sp. (MSX 51320).” Arlene A. Sy-Cordero, Tyler N. Graf, Audrey F. Adcock, David J. Kroll, Qi Shen, Steven M. Swanson, Mansukh C. Wani, Cedric J. Pearce, and Nicholas H. Oberlies Journal of Natural Products, 2011, 74, 2137-2142. PMID:21978324; doi: 10.1021/np2004243 “Correction to Cyclodepsipeptides, Sesquiterpenoids, and Other Cytotoxic Metabolites from the Filamentous Fungus Trichothecium sp. (MSX 51320).” Arlene A. Sy-Cordero, Tyler N. Graf, Audrey F. Adcock, David J. Kroll, Qi Shen, Steven M. Swanson, Mansukh C. Wani, Cedric J. Pearce, and Nicholas H. Oberlies Journal of Natural Products, 2012, 75, 307-307. doi: 10.1021/np3000766 |
| 62 | “Fingolimod (FTY720): A Recently Approved Multiple Sclerosis Drug Based on a Fungal Secondary Metabolite.” Cherilyn R. Strader, Cedric J. Pearce, and Nicholas H. Oberlies Journal of Natural Products, 2011, 74, 900-907. PMID:21456524; doi: 10.1021/np2000528 |
| 61 | “Romidepsin (Istodax, NSC 630176, FR901228, FK228, Depsipeptide): A Natural Product Recently Approved for Cutaneous T-Cell Lymphoma.” Karen M. VanderMolen, William McCulloch, Cedric J. Pearce, and Nicholas H. Oberlies Journal of Antibiotics, 2011, 64, 525-531. PMID: 21587264; PMCID: PMC3163831; doi: 10.1038/ja.2011.35 |
2010
| 60 | “The Warfarin-Cranberry Juice Interaction Revisited: A Systematic in Vitro-in Vivo Evaluation.” Ngoc Ngo, Scott J. Brantley, Daniel R. Carrizosa, Angela D. M. Kashuba, E. Claire Dees, David J. Kroll, Nicholas H. Oberlies, and Mary F. Paine Journal of Experimental Pharmacology, 2010, 2, 83-91. PMID:20865058; PMCID: PMC2943398; doi: 10.2147/JEP.S11719 |
| 59 | “Colchicinoids from Colchicum Crocifolium Boiss. (Colchicaceae).” Feras Q. Alali, Ahmad A. Gharaibeh, Abdullah Ghawanmeh, Khaled Tawaha, Amjad Qandil, Jason P. Burgess, Arlene Sy, Yuka Nakanishi, David J. Kroll, and Nicholas H. Oberlies Natural Product Research, 2010, 24, 152-159. PMID:20077308; doi: 10.1080/14786410902941097 |
| 58 | “A Randomized, Controlled, Double-Blind, Pilot Study of Milk Thistle for the Treatment of Hepatotoxicity in Childhood Acute Lymphoblastic Leukemia (ALL).” Elena J. Ladas, David J. Kroll, Nicholas H. Oberlies, Bin Cheng, Deborah H. Ndao, Susan R. Rheingold, and Kara M. Kelly Cancer, 2010, 116, 506-513. PMID: 20014183; doi: 10.1002/cncr.24723 |
| 57 | “Dereplication of Macrocyclic Trichothecenes from Extracts of Filamentous Fungi through UV and NMR Profiles.” Arlene A. Sy-Cordero, Tyler N. Graf, Mansukh C. Wani, David J. Kroll, Cedric J. Pearce, and Nicholas H. Oberlies Journal of Antibiotics, 2010, 63, 539-544. PMID:20648023; PMCID: PMC2946446; doi: 10.1038/ja.2010.77 |
| 56 | “Multiple Effects of Silymarin on the Hepatitis C Virus Lifecycle.” Jessica Wagoner, Amina Negash, Olivia J. Kane, Laura E. Martinez, Yaakov Nahmias, Nigel Bourne, David M. Owen, Joe Grove, Claire Brimacombe, Jane A. McKeating, Eve-Isabelle Pécheur, Tyler N. Graf, Nicholas H. Oberlies, Volker Lohmann, Feng Cao, John E. Tavis, and Stephen J. Polyak Hepatology, 2010, 51, 1912-1921. PMID:20512985; PMCID: PMC2909978; doi: 10.1002/hep.23587 |
| 55 | “Identification of Hepatoprotective Flavonolignans from Silymarin.” Stephen J. Polyak, Chihiro Morishima, Volker Lohmann, Sampa Pal, David Y. W. Lee, Yanze Liue, Tyler N. Graf, and Nicholas H. Oberlies Proceedings of the National Academy of Sciences USA, 2010, 107, 5995-5999. PMID: 20231449; PMCID: PMC2851903; doi: 10.1073/pnas.0914009107 |
| 54 | “Two Flavonolignans from Milk Thistle (Silybum marianum) Inhibit CYP2C9-Mediated Warfarin Metabolism at Clinically Achievable Concentrations.” Scott J. Brantley, Nicholas H. Oberlies, David J. Kroll, and Mary F. Paine Journal of Pharmacology and Experimental Therapeutics, 2010, 332, 1081-1087. PMID:19934397; PMCID: PMC2835426; doi: 10.1124/jpet.109.161927 |
| 53 | “Large-Scale Isolation of Flavonolignans from Silybum marianum Extract Affords New Minor Constituents and Preliminary Structure-Activity Relationships.” Arlene Sy-Cordero, Tyler N. Graf, Yuka Nakanishi, Mansukh C. Wani, Rajesh Agarwal, David J. Kroll, and Nicholas H. Oberlies Planta Medica, 2010, 76, 644-647. PMID:19941262; PMCID: PMC2910627; doi: 10.1055/s-0029-1240624 |
| 52 | “Isosilybin A Induces Apoptosis in Human Prostate Cancer Cells Via Targeting Akt, NF-kappaB, and Androgen Receptor Signaling.” Gagan Deep, Subhash C. Gangar, Nicholas H. Oberlies, David J. Kroll, and Rajesh Agarwal Molecular Carcinogenesis, 2010, 49, 902-912. PMID:20721970; doi: 10.1002/mc.20670 |
| 51 | “Silymarin Inhibits in Vitro T Cell Proliferation and Cytokine Production in Hepatitis C Virus Infection.” Chihiro Morishima, Margaret C. Shuhart, Chia C. Wang, Denise M. Paschal, Minjun C. Apodaca, Yanze Liu, Derek D. Sloan, Tyler N. Graf, Nicholas H. Oberlies, David Y.–W. Lee, Keith R. Jerome, and Stephen J. Polyak Gastroenterology, 2010, 138, 671-681. PMID:19782083; PMCID: PMC2819600; doi: 10.1053/j.gastro.2009.09.021 |
| 50 | “Influence of Dietary Substances on Intestinal Drug Metabolism and Transport.” Christina S. Won, Nicholas H. Oberlies, and Mary F. Paine Current Drug Metabolism, 2010, 11, 778-792. PMID: 21189136; PMCID: PMC3034088; Link to free version |
2009
| 49 | “Mapping of Sample Collection Data: Gis Tools for the Natural Product Researcher.” Nicholas H. Oberlies, James I. Rineer, Feras Q. Alali, Khaled Tawaha, Joseph O. Falkinham III, and William D. Wheaton Phytochemistry Letters, 2009, 2, 1-9. PMID: 20161345; PMCID: PMC2774915; doi: 10.1016/j.phytol.2008.10.006 |
| 48 | “Identification of a Cranberry Juice Product That Inhibits Enteric CYP3A-Mediated First-Pass Metabolism in Humans.” Ngoc Ngo, Zhixia Yan, Tyler N. Graf, Daniel R. Carrizosa, Angela D. M. Kashuba, E. Claire Dees, Nicholas H. Oberlies, and Mary F. Paine Drug Metabolism and Disposition, 2009, 37, 514-522. PMID: 19114462; PMCID: PMC2650736; doi: 10.1124/dmd.108.024968 |
| 47 | “Proliferation of Antibiotic Producing Bacteria and Concomitant Antibiotic Production as the Basis for the Antibiotic Activity of Jordan’s Red Soils.” Joseph O. Falkinham III, Thomas E. Wall, Justin R. Tanner, Khaled Tawaha, Feras Q. Alali, Chen Li, and Nicholas H. Oberlies Applied and Environmental Microbiology, 2009, 75, 2735-2741. PMID: 19286796; PMCID: PMC2681674; doi: 10.1128/AEM.00104-09 |
| 46 | “Bioactive Constituents of the Stem Bark of Mitrephora Glabra.” Chen Li, Dongho Lee, Tyler N. Graf, Sharnelle S. Phifer, Yuka Nakanishi, Soedarsono Riswan, Fransisca M. Setyowati, Achmad M. Saribi, Djaja D. Soejarto, Norman R. Farnsworth, III Joseph O. Falkinham III, David J. Kroll, A. Douglas Kinghorn, Mansukh C. Wani, and Nicholas H. Oberlies Journal of Natural Products, 2009, 72, 1949-1953. PMID: 19874044; PMCID: PMC2862477; doi: 10.1021/np900572g |
| 45 | “Discovery of Anticancer Agents of Diverse Natural Origin.” A. Douglas Kinghorn, Esperanza J. Carcache de Blanco, Hee-Byung Chai, Jimmy Orjala, Norman R. Farnsworth, D. Doel Soejarto, Nicholas H. Oberlies, Mansukh C. Wani, David J. Kroll, Cedric J. Pearce, Steven M. Swanson, Robert A. Kramer, William C. Rose, Craig R. Fairchild, Gregory D. Vite, Stuart Emanuel, David Jarjoura, and Frederick O. Cope Pure Applied Chemistry, 2009, 81, 1051-1063. PMID: 20046887; PMCID: PMC2765058; doi: 10.1351/PAC-CON-08-10-16 |
2008
| 44 | “Microbial-Mediated Release of Bisphenol A from Polycarbonate Vessels.” Nicholas H. Oberlies, Chen Li, Robert J. McGivney, Feras Q. Alali, Justin R. Tanner, and Joseph O. Falkinham III Letters in Applied Microbiology, 2008, 46, 271-275. PMID:18069976; doi: 10.1111/j.1472-765X.2007.02301.x |
| 43 | “Colchicinoids from Colchicum Crocifolium Boiss.: A Case Study in Dereplication Strategies for (-)-Colchicine and Related Analogs Using LC-MS and LC-PDA Techniques.” Feras Q. Alali, Ahmad Gharaibeh, Abdullah Ghawanmeh, Khaled Tawaha, and Nicholas H. Oberlies Phytochemical Analysis, 2008, 19, 385-394. PMID: 18444231; doi: 10.1002/pca.1060 |
| 42 | “Isosilibinin Inhibits Advanced Human Prostate Cancer Growth in Athymic Nude Mice: Comparison with Silymarin and Silibinin.” Gagan Deep, Komal Raina, Rana P. Singh, Nicholas H. Oberlies, David J. Kroll, and Rajesh Agarwal International Journal of Cancer, 2008, 123, 2750-2758. PMID:18798272; doi: 10.1002/ijc.23879 |
| 41 | “Identifying the Differential Effects of Silymarin Constituents on Cell Growth and Cell Cycle Regulatory Molecules in Human Prostate Cancer Cells.” Gagan Deep, Nicholas H. Oberlies, David J. Kroll, and Rajesh Agarwal International Journal of Cancer, 2008, 123, 41-50. PMID:18435416; doi: 10.1002/ijc.23485 |
| 40 | “Isosilybin B Causes Androgen Receptor Degradation in Human Prostate Carcinoma Cells Via PI3K-Akt-Mdm2-Mediated Pathway.” Gagan Deep, Nicholas H. Oberlies, David J. Kroll, and Rajesh Agarwal Oncogene, 2008, 27, 3986-3998. PMID: 18332867; doi: 10.1038/onc.2008.45 |
| 39 | “Pyrrolizidine Alkaloids from Echium glomeratum (Boraginaceae).” Feras Q. Alali, Yahya R. Tahboub, Eyad S. Ibrahim, Amjad M. Qandil, Khaled Tawaha, Jason P. Burgess, Arlene Sy, Yuka Nakanishi, David J. Kroll, and Nicholas H. Oberlies Phytochemistry, 2008, 69, 2341-2346. PMID:18691727; doi: 10.1016/j.phytochem.2008.06.017 |
2007
| 38 | “A Novel Small Molecule That Selectively Inhibits Glioblastoma Cells Expressing EGFRvIII.” Dimitri G. Trembath, Anita Lal, David J. Kroll, Nicholas H. Oberlies, and Gregory J. Riggins Molecular Cancer, 2007, 6, 30. PMID: 17437646; PMCID: PMC1855066; doi: 10.1186/1476-4598-6-30 |
| 37 | “Antioxidant Activity and Total Phenolic Content of Aqueous and Methanolic Extracts of Jordanian Plants: An ICBG Project.” Feras Q. Alali, Khaled Tawaha, Tamam El-Elimat, Maha Syouf, Mosa El-Fayad, Khaled Abulaila, Samara Joy Nielsen, William D. Wheaton, Joseph O. Falkinham III, and Nicholas H. Oberlies Natural Product Research, 2007, 21, 1121-1131. PMID: 17852749; doi: 10.1080/14786410701590285 |
| 36 | “Isosilybin B and Isosilybin A Inhibit Growth, Induce G1 Arrest and Cause Apoptosis in Human Prostate Cancer LNCaP and 22Rv1 Cells.” Gagan Deep, Nicholas H. Oberlies, David J. Kroll, and Rajesh Agarwal Carcinogenesis, 2007, 28, 1533-1542. PMID: 17389612; doi: 10.1093/carcin/bgm069 |
| 35 | “Development of a Fluorescence-Based Assay to Screen Antiviral Drugs against Kaposi’s Sarcoma Associated Herpesvirus.” Tamara K. Nun, David J. Kroll, Nicholas H. Oberlies, Djaja D. Soejarto, Ryan J. Case, Pius Piskaut, Teatulohi Matainaho, Chelsey Hilscher, Ling Wang, Dirk P. Dittmer, Shou-Jian Gao, and Blossom Damania Molecular Cancer Therapeutics, 2007, 6, 2360-2370. PMID: 17699731; doi: 10.1158/1535-7163.MCT-07-0108 |
| 34 | “Variability in the Yield of Benzophenanthridine Alkaloids in Wildcrafted vs Cultivated Bloodroot (Sanguinaria canadensis L.).” Tyler N. Graf, Keith E. Levine, Margaret E. Andrews, Jason M. Perlmutter, Samara Joy Nielsen, Jeanine M. Davis, Mansukh C. Wani, and Nicholas H. Oberlies Journal of Agricultural and Food Chemistry, 2007, 55, 1205-1211. PMID: 17253712; doi: 10.1021/jf062498f |
| 33 | “Alvaradoins E-N, Antitumor and Cytotoxic Anthracenone C-Glycosides from the Leaves of Alvaradoa haitiensis.” Sharnelle S. Phifer, Dongho Lee, Eun-Kyoung Seo, Nam-Cheol Kim, Tyler N. Graf, David J. Kroll, Hernán A. Navarro, Robert A. Izydore, Francisco Jiménez, Ricardo Garcia, William C. Rose, Craig R. Fairchild, Robert Wild, Djaja D. Soejarto, Norman R. Farnsworth, A. Douglas Kinghorn, Nicholas H. Oberlies, Monroe E. Wall, and Mansukh C. Wani Journal of Natural Products, 2007, 70, 954-961. PMID: 17552563; PMCID: PMC2442713; doi: 10.1021/np070005a |
| 32 | “Gram-Scale Purification of Flavonolignan Diastereoisomers from Silybum marianum (Milk Thistle) Extract in Support of Preclinical in Vivo Studies for Prostate Cancer Chemoprevention.” Tyler N. Graf, Mansukh C. Wani, Rajesh Agarwal, David J. Kroll, and Nicholas H. Oberlies Planta Medica, 2007, 73, 1495-1501. PMID: 17948171; doi: 10.1055/s-2007-990239 |
| 31 | “Milk Thistle Nomenclature: Why It Matters in Cancer Research and Pharmacokinetic Studies.” David J. Kroll, Heather S. Shaw, and Nicholas H. Oberlies Integrative Cancer Therapies, 2007, 6, 110-119. PMID: 17548790; doi: 10.1177/1534735407301825 |
| 30 | “Clinical Relevance of the Small Intestine as an Organ of Drug Elimination: Drug-Fruit Juice Interactions.” Mary F. Paine, and Nicholas H. Oberlies Expert Opinion on Drug Metabolism & Toxicology, 2007, 3, 67-80. PMID: 17269895; doi: 10.1517/17425255.3.1.67 |
2006
| 29 | “A New Colchicinoid from Colchicum tauri, an Unexplored Meadow Saffron Native to Jordan.” Feras Q. Alali, Amani S. Ma’aya’h, Ahmad Alkofahi, Amjad Qandil, Chen Li, Jason P. Burgess, Mansukh C. Wani, and Nicholas H. Oberlies Natural Product Communications, 2006, 1, 95-99. |
| 28 | “Phytochemical Studies and Cytotoxicity Evaluations of Colchicum tunicatum Feinbr and Colchicum hierosolymitanum Feinbr (Colchicaceae): Two Native Jordanian Meadow Saffrons.” Feras Q. Alali, Khaled Tawaha, Tamam El-Elimat, Rana Qasaymeh, Chen Li, Jason Burgess, Yuka Nakanishi, David J. Kroll, Mansukh C. Wani, and Nicholas H. Oberlies Natural Product Research, 2006, 20, 558-566. PMID: 16835088; doi: 10.1080/14786410500183381 |
| 27 | “Dendrimer-Encapsulated Camptothecins: Increased Solubility, Cellular Uptake, and Cellular Retention Affords Enhanced Anticancer Activity in Vitro.” Meredith T. Morgan, Yuka Nakanishi, David J. Kroll, Aaron P. Griset, Michael A. Carnahan, Michel Wathier, Nicholas H. Oberlies,Govindarajan Manikumar, Mansukh C. Wani, and Mark W. Grinstaff Cancer Research, 2006, 66, 11913-11921. PMID: 17178889; doi: 10.1158/0008-5472.CAN-06-2066 |
| 26 | “Simple and Inexpensive Methods to Prevent Botanical Misfortune.” David J. Kroll, Heather S. Shaw, and Nicholas H. Oberlies Acta Horticulturae, 2006, 720, 137-147. https://www.actahort.org/books/720/720_13.htm |
2005
| 25 | “New Colchicinoids from a Native Jordanian Meadow Saffron, Colchicum brachyphyllum: Isolation of the First Naturally Occurring Dextrorotary Colchicinoid.” Feras Q. Alali, Tamam El-Elimat, Chen Li, Amjad Qandil, Ahmad Alkofahi, Khaled Tawaha, Jason P. Burgess, Yuka Nakanishi, David J. Kroll, Hernán A. Navarro, III Joseph O. Falkinham III, Mansukh C. Wani, and Nicholas H. Oberlies Journal of Natural Products, 2005, 68, 173-178. PMID: 15730238; doi: 10.1021/np0496587 |
| 24 | “Diterpene Glycosides from Egletes viscosa.” Dongho Lee, Chen Li, Tyler N. Graf, Jose Schunke Vigo, James G. Graham, Fernando Cabieses, Norman R. Farnsworth, Geoffrey A. Cordell, A. Douglas Kinghorn, David J. Kroll, Mansukh C. Wani, and Nicholas H. Oberlies Planta Medica, 2005, 71, 792-794. PMID: 16142652; doi: 10.1055/s-2005-871227 |
| 23 | “A Hexacyclic Ent-Trachylobane Diterpenoid Possessing an Oxetane Ring from Mitrephora Glabra.” Chen Li, Dongho Lee, Tyler N. Graf, Sharnelle S. Phifer, Yuka Nakanishi, Jason P. Burgess, Soedarsono Riswan, Fransisca M. Setyowati, Achmad M. Saribi, Djaja D. Soejarto, Norman R. Farnsworth, Joseph O. Falkinham III, David J. Kroll, A. Douglas Kinghorn, Mansukh C. Wani, and Nicholas H. Oberlies Organic Letters, 2005, 7, 5709-5712. PMID: 16321028; PMCID: PMC2442714; doi: 10.1021/ol052498l |
| 22 | “Milk Thistle and Prostate Cancer: Differential Effects of Pure Flavonolignans from Silybum marianum on Antiproliferative End Points in Human Prostate Carcinoma Cells.” Paula R. Davis-Searles, Yuka Nakanishi, Nam-Cheol Kim, Tyler N. Graf, Nicholas H. Oberlies, Mansukh C. Wani, Monroe E. Wall, Rajesh Agarwal, and David J. Kroll Cancer Research, 2005, 65, 4448-4457. PMID: 15899838; doi: 10.1158/0008-5472.CAN-04-4662 |
| 21 | “The Most Widely Recognized Mushroom: Chemistry of the Genus Amanita.” Chen Li, and Nicholas H. Oberlies Life Sciences, 2005, 78, 532-538. PMID: 16203016; doi: 10.1016/j.lfs.2005.09.003 |
2004
| 20 | “Analysis of Herbal Teas Made from the Leaves of Comfrey (Symphytum officinale): Reduction of N-Oxides Results in Order of Magnitude Increases in the Measurable Concentration of Pyrrolizidine Alkaloids.” Nicholas H Oberlies, Nam-Cheol Kim, Dolores R Brine, Bradley J Collins, Robert W Handy, Charles M Sparacino, Mansukh C Wani, and Monroe E Wall Public Health Nutrition, 2004, 7, 919-924. PMID: 15482618; doi: 10.1079/PHN2004624 |
| 19 | “Cytotoxic and Antimicrobial Constituents of the Bark of Diospyros maritima Collected in Two Geographical Locations in Indonesia.” Jian-Qiao Gu, Tyler N. Graf, Dongho Lee, Hee-Byung Chai, Qiuwen Mi, Leonardus B. S. Kardono, Fransisca M. Setyowati, Rachman Ismail, Soedarsono Riswan, Norman R. Farnsworth, Geoffrey A. Cordell, John M. Pezzuto, Steven M. Swanson, David J. Kroll, Joseph O. Falkinham III, Monroe E. Wall, Mansukh C. Wani, A. Douglas Kinghorn, and Nicholas H. Oberlies Journal of Natural Products, 2004, 67, 1156-1161. PMID: 15270571; doi: 10.1021/np040027m |
| 18 | “Camptothecin and Taxol: Historic Achievements in Natural Products Research.” Nicholas H. Oberlies, and David J. Kroll Journal of Natural Products, 2004, 67, 129-135. PMID: 14987046; doi: 10.1021/np030498t |
2003
| 17 | “Synergistic Antimicrobial Activity of Metabolites Produced by a Nonobligate Bacterial Predator.” Cody C. Cain, Dongho Lee, Robert H. Waldo III, Alexis T. Henry, Earl J. Casida Jr., Mansukh C. Wani, Monroe E. Wall, Nicholas H. Oberlies, and Joseph O. Falkinham III Antimicrobial Agents and Chemotherapy, 2003, 47, 2113-2117. PMID: 12821455; PMCID: PMC161883; doi: 10.1128/AAC.47.7.2113-2117.2003 |
| 16 | “Novel Strategies for the Discovery of Plant-Derived Anticancer Agents.” A. Kinghorn, Norman Farnsworth, Djaja Soejarto, Geoffrey Cordell, Steven Swanson, John Pezzuto, Mansukh Wani, Monroe Wall, Nicholas Oberlies, David Kroll, Robert Kramer, William Rose, Gregory Vite, Craig Fairchild, Russell Peterson, and Robert Wild Pharmaceutical Biology, 2003, 41 (Suppl.), 53-67. doi: 10.1080/1388020039051744 |
2002
| 15 | “Novel Bioactive Clerodane Diterpenoids from the Leaves and Twigs of Casearia sylvestris.” Nicholas H. Oberlies, Jason P. Burgess, Hernán A. Navarro, Rosa Elena Pinos, Craig R. Fairchild, Russell W. Peterson, Djaja D. Soejarto, Norman R. Farnsworth, A. Douglas Kinghorn, Mansukh C. Wani, and Monroe E. Wall Journal of Natural Products, 2002, 65, 95-99. PMID: 11858737; doi: 10.1021/np010459m |
2001
| 14 | “Bioactive Constituents of the Roots of Licania intrapetiolaris.” Nicholas H. Oberlies, Jason P. Burgess, Hernán A. Navarro, Rosa Elena Pinos, Djaja D. Soejarto, Norman R. Farnsworth, A. Douglas Kinghorn, Mansukh C. Wani, and Monroe E. Wall Journal of Natural Products, 2001, 64, 497-501. PMID: 11325234; doi: 10.1021/np0005006 |
| 13 | “Isolation of Symlandine from the Roots of Common Comfrey (Symphytum officinale) Using Countercurrent Chromatography.” Nam-Cheol Kim, Nicholas H. Oberlies, Dolores R. Brine, Robert W. Handy, Mansukh C. Wani, and Monroe E. Wall Journal of Natural Products, 2001, 64, 251-253. PMID: 11430014; doi: 10.1021/np0004653 |
1998
| 12 | “Cytotoxic and Insecticidal Constituents of the Unripe Fruit of Persea americana.” Nicholas H. Oberlies, Lingling L. Rogers, John M. Martin, and Jerry L. McLaughlin Journal of Natural Products, 1998, 61, 781-785. PMID: 9644064; doi: 10.1021/np9800304 |
| 11 | “Myosin Isoform Shifts and Decreased Reactivity in Hypoxia-Induced Hypertensive Pulmonary Arterial Muscle.” C. Subah Packer, Janet E. Roepke, Nicholas H. Oberlies, and Rodney A. Rhoades American Journal of Physiology, 1998, 274, L775-L785. PMID: 9612293; doi: 10.1152/ajplung.1998.274.5.L775 |
1997
| 10 | “The Annonaceous Acetogenin Bullatacin Is Cytotoxic against Multidrug Resistant Human Mammary Adenocarcinoma Cells.” Nicholas H. Oberlies, Vicki L. Croy, Marietta L. Harrison, and Jerry L. McLaughlin Cancer Letters, 1997, 115, 73-79. PMID: 9097981; doi: 10.1016/S0304-3835(97)04716-2 |
| 9 | “Comparative SAR Evaluations of Annonaceous Acetogenins for Pesticidal Activity.” Kan He, Lu Zeng, Qing Ye, Guoen Shi, Nicholas H. Oberlies, Geng-Xian Zhao, C. Jesse Njoku, and Jerry L. McLaughlin Pesticide Science, 1997, 49, 372-379. doi: 10.1002/(SICI)1096-9063(199704)49:4<372::AID-PS543>3.0.CO;2-K |
| 8 | “Oleanolic Acid, a Bioactive Component of the Leaves of Ocimum gratissimum (Lamiaceae).” C.J. Njoku, Lu Zeng, I.U. Asuzu, Nicholas H. Oberlies, and Jerry L. McLaughlin International Journal of Pharmacognosy, 1997, 35, 134-137. doi: 10.1076/phbi.35.2.134.13290 |
| 7 | “Structure-Activity Relationships of Diverse Annonaceous Acetogenins against Multidrug Resistant Human Mammary Adenocarcinoma (MCF-7/Adr) Cells.” Nicholas H. Oberlies, Ching-jer Chang, and Jerry L. McLaughlin Journal of Medicinal Chemistry, 1997, 40, 2102-2106. PMID: 9207950; doi: 10.1021/jm9700169 |
1996
| 6 | “Longimicins A-D: Novel Bioactive Acetogenins from Asimina longifolia (Annonaceae), and Structure Activity Relationships of Asimicin Type Annonaceous Acetogenins.” Qing Ye, Kan He, Nicholas H. Oberlies, Lu Zeng, Guoen Shi, Dean Evert, and Jerry L. McLaughlin Journal of Medicinal Chemistry, 1996, 39, 1790-1796. PMID: 8627602; doi: 10.1021/jm9600510 |
| 5 | “Five New Monotetrahydrofuran Ring Acetogenins from the Leaves of Annona muricata.” Lu Zeng, Feng-E Wu, Nicholas H. Oberlies, and Jerry L. McLaughlin Journal of Natural Products, 1996, 59, 1035-1042. PMID: 8946744; doi: 10.1021/np960447e |
| 4 | “Recent Advances in Annonaceous Acetogenins.” Lu Zeng, Qing Ye, Nicholas H. Oberlies, Guoen Shi, Zhe-Ming Gu, Kan He, and Jerry L. McLaughlin Natural Products Reports, 1996, 13, 275-306. PMID: 8760865; doi: 10.1039/NP9961300275 |
1995
| 3 | “Tumor Cell Growth Inhibition by Several Annonaceous Acetogenins in an in Vitro Disk Diffusion Assay.” Nicholas H. Oberlies, Julie L. Jones, Thomas H. Corbett, Sophia S. Fotopoulos, and Jerry L. McLaughlin Cancer Letters, 1995, 96, 55-62. PMID: 7553608; doi: 10.1016/0304-3835(95)92759-7 | ![]() |
| 2 | “Mode of Action of Bullatacin, a Potent Antitumor Acetogenin: Inhibition of NADH Oxidase Activity of HeLa and HL-60, but Not Liver, Plasma Membranes.” D. James Morré, Rafael de Cabo, Christopher Farley, Nicholas H. Oberlies, and Jerry L. McLaughlin Life Sciences, 1995, 56, 343-348. PMID: 7837933; doi: 10.1016/0024-3205(94)00957-0 | ![]() |
1993
| 1 | “The Electrochemical Preparation and Kinetic and Product Studies of Acylated Quinol and Quinol Ether Imines – in Search of the Hydrolysis Products of the Ultimate Carcinogen of N-Acetyl-2-Aminofluorene.” Michael Novak, John S. Helmick, Nicholas Oberlies, Kanchugarakoppal S. Rangappa, William M. Clark, and John S. Swenton Journal of Organic Chemistry, 1993, 58, 867-878. doi: 10.1021/jo00056a019 |